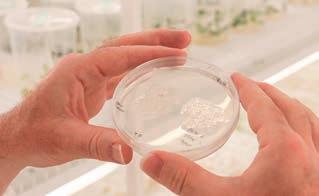

We celebrate 5 years of 4TU Career Special with an extra thick lustrum issue
Take
OPENING STORY
WIL MICHELS AND THE CHANGED JOB MARKET
COVER STORY
WUR-ALUMNA STERRIN
SMALBRUGGE ABOUT HER CAREER AS A WRITER, PRESENTER AND RESEARCHER
WILDLIFE ECOLOGY
INTERVIEW
CAREER COUNSELLOR

CLAIRE VISÉE: ‘REGARDING
EMPLOYEE BENEFITS, NEGOTIATION IS INHERENT’

JUNE 2023, ISSUE #5 CAREER SPECIAL
LUSTRUM EDITION!
advantage of the changed job market
This 4TU Career Special is a shared publication by the news editors of Cursor (Eindhoven University of Technology), Delta (Delft University of Technology), Resource (Wageningen University and Research), and U-Today (University of Twente). The magazine came into being in collaboration with industry, and is explicitly aimed towards students who are either in the final phase of their studies, or have just graduated.
COORDINATOR / EDITOR IN CHIEF OF THE CAREER SPECIAL Sandra Pool, U-Today
CONTRIBUTORS Saskia Bonger (editor-in-chief Delta); Willem Andree (editor-in-chief Resource); Han Konings (editor-in-chief Cursor); Maaike Platvoet (editor-in-chief U-Today); Ditta op den Dries (final-editor U-Today) and (freelance) editors Elke Agten, Peter Koehorst, Bauke Vermaas, Marieke Enter, Rob van der Wal, and the Alumni Network UT, TU/e, WUR and TU
TRANSLATORS Daans Assies and Vinent Boon


ADVERTISEMENTS Princetown Media, Marc Nühn
COVER PHOTO Óscar Lopez LAY OUT AND REALISATION Schuttersmagazijn, www.schuttersmagazijn.nl
DO YOU WANT TO ADVERTISE WITH US? Send an email to specials-utoday@utwente.nl.
DID YOU CHANGE YOUR ADDRESS, OR DO YOU NO LONGER WISH TO RECEIVE POST FROM US? Mail to: alumni@tue.nl / alumnirelations@tudelft.nl / alumni@utwente.nl / alumni@wur.nl
COPYRIGHT @2023 U-TODAY Nothing in this publication can be duplicated, be it through print, photocopying, automated databases, or in any other way possible, without the explicit consent of U-Today.
PRINT RUN 14.000 copies were sent via post to those students who have recently graduated, and 500 were spread on each campus.
CONTENT
PLAEX 25 BOLDWAV 71 UNPLUQ 47 SEWOB 45 ZWAMCIJSJE 55 DUTCHDATABUSTERS 67 COLOPHON S START-UP
15
DANIEL HAGMEIJER

(TU DELFT): CMO AT THE BODY SHOP INDONESIA

36
STERRIN SMALBRUGGE
(WUR): ‘MY AIM WAS TO GRADUATE WITH DISTINCTION’
49
HENK ARNTZ (TU/E): BIG AMBITIONS IN SUSTAINABILITY
74 ALUMNUS COLUMN
C
27
VISHAL ONKHAR (TU DELFT): THE PARADOX OF CHOICE

19
BORED AT WORK? THAT DOESN’T HAVE TO BE A BAD THING
6
OPENING STORY: ‘THE POWER DYNAMICS ON THE JOB MARKET HAVE TRULY CHANGED’
NIELS TER MEER (UT): CAREER LEOPARD
73 10
16 28
32
REGARDING EMPLOYEE BENEFITS: ‘NEGOTIATION IS INHERENT’
22
THE NEW APPROACH TO JOB APPLICATIONS: ASK QUESTIONS
62
76
‘DISCOVER WHAT FIRES YOU UP AND GET NOTICED FOR IT’
INCLUSION IN THE WORKPLACE
TIM VAN DE RIJDT (UT): DANCING ALONG AT MOSA MEAT A FEA TUR ED!









WeEngineer CareersTMC themembercompany.com
Dreams and ambitions
The good news is that the current job market is a seller’s market, especially for graduates from universities of technology. But too much choice can be daunting, so it is best to look before you leap.
A lot has changed since I entered the workforce back in the 1980’s and much more will change in the coming years. Back then, the focus was still very much on industrial and economic development, while we now realise the need for sustainability and a fairer distribution of wealth. We need to work on combating the impact of climate change, and on making societies around the world more resilient. That
requires a very different mind-set, and one I recognise in our students today. At the same time, rapid technological developments are causing the labour market to change at an unprecedented pace. For instance, how will the recent emergence of large language models like ChatGPT affect the way we work in 5 or 10 years’ time?
So what career advice can I give you?
Personally, I feel I’ve been privileged. Spending my career at a university, I experienced that sense of infinite possibilities throughout the years. Science involves looking forward, breaking new ground and making discoveries. Being in the company of young people with
inquisitive minds gave me a sense of optimism and hope for the future. I was able to follow my heart and enjoyed (almost) every day.
Ultimately, it’s all about you and your dreams and ambitions. As a 4TU graduate, you have the knowledge and skills to achieve success in many fields, but first steps are never easy. So in this Career Special, you will find stories of graduates who have preceded you, of start-ups who have launched their own businesses and of employers who might have that dream position for you. I hope they will help and inspire you.
Tim van der Hagen

Your student years are a time of infinite possibilities. You immerse yourself in new subjects, acquire knowledge, make new friends and prepare for your professional career. Now you are about to embark on that career.
TIM VAN DER HAGEN RECTOR MAGNIFICUS TU DELFT FOREWORD F 5 CAREER SPECIAL 01/2023
‘The power dynamics on the job market have truly changed’

Every academic year, universities compete to bring in new students. As soon as another batch has graduated, companies are eagerly waiting at the gate to take them on as their new employees. Although that certainly doesn’t happen automatically any more. ‘Young people mainly want to feel at home somewhere,’ says Wil Michels, lecturer and best-selling author of the books like Fanstrategie [Fan Strategy].
Newcomers to the labour market are looking for an attractive employer more than ever. Michels: ‘They want to do meaningful work and feel a strong connection with the company they work for. A company must therefore, above all, have a good ‘story’ that applicants can identify with. Moreover, today’s young employee goes for a permanent contract with a lot of freedom, for
example when it comes to arranging their own working hours and leave to work remotely. Companies should better make sure that they are an attractive employer, because the power no longer lies with the company, but with the job applicant,’ is how Michels outlines the situation in the job market . ‘It is no longer a matter of ‘we ask’, but ‘what do you offer’ an applicant.’
TOO FEW APPLICANTS
Society is changing rapidly and its effects are being felt in many sectors, according to Michels. ‘Take the healthcare sector, for example. There are lots of vacancies, but far too few applicants. When planning to build a new hospital, the legitimate question then arises: who will actually work in this new hospital? Because staff is hard to come by.’ The same problem occurs within many industries. Michels tells of a cleaning company like CSU where 1,000 people leave every year while only 500 enter in
6
WIL MICHELS
TEXT DITTA OP DEN DRIES PHOTO OWN PICTURES
I
OPENING STORY
their place. ‘And take ASML Veldhoven. It can attract up to 800 new employees a month, but there are simply not that many potential employees.’
FAN STRATEGY

Anyone who might think that Michels is a pessimist is dead wrong. According to him, the battle for motivated employees is not a lost battle. Far from it! Michels has a mission. In his book Fanstrategie, he describes how companies and graduates can find each other better. He gives guest lectures and workshops at universities and in the business world to inspire (future) employers and employees. For instance, he trained communication staff at TU Delft and will soon visit Wageningen University.
‘Universities are often functional and content-oriented when it comes to student recruitment. But the emotional side is at least as important. Every student should feel, this where I want to be! That is why universities should especially reinforce and propagate what they do well and what they are proud of. Not modestly, no....it should shine! Proud of your new solar car? Wear it out. Shout it from the rooftops. That’s where we all really have a battle to make. In America, there are 50,000 people cheering for a university team. Sport is emotion. In the Netherlands we have to do that differently. The more you show your individuality in it, the better. Fan strategy is all about emotion and identification. If we want to bind our fans, we can all be much more creative in this. Success starts with creating internal fans.’
INDUSTRY
The industry should also use all the creativity there is to hire new staff. Michels: ‘There are so many ideas for that. Show that you are a fun company and dare to go all out for it. Maybe even hire a chief happiness. Make ten videos of employees being super-enthusiastic about the company or take part in a challenge or sports competition as a company team.’
He knows a company that, every second Saturday in September, takes employees and their families to eat chips at the Rotterdam Zoo. ‘A wonderful initiative,’ Michels thinks. ‘If you set up an activity like this, you could, for instance, count down together: three more weeks, two more days.... just one more day! That way, you make it fun and ensure that everyone sees it as a very special day. Of course, you also create great content for your socials.’
WIL MICHELS TEACHES COMMUNICATION AT THE UNIVERSITY OF ANTWERP AND AT TRAINING INSTITUTE NCOI. HE WORKS AT THE COMPANY VAN DER HILST AND GIVES WORKSHOPS, WEBINARS AND GUEST LECTURES ON COMMUNICATION STRATEGY. MICHELS IS BESTSELLING AUTHOR OF HET HANDBOEK COMMUNICATIE [HANDBOOK ON COMMUNICATION], HET COMMUNICATIE MODEL [THE COMMUNICATION MODEL] AND FANSTRATEGIE [FAN STRATEGY].
‘Companies and institutions really need to work on giving employees/students that family feeling. Sometimes this is in something small, sometimes it costs money, but high turnover and advertising costs much more. And once you are a fan of a company or institution, one stays loyal for longer.’
Do you also want to follow a Fanstrategie session? Mail to: wil@michelscommunicatie.nl
‘The power no longer lies with the company, but with the job applicant’
7
CAREER SPECIAL 01/2023
Gezocht: onderzoekers met brede maatschappelijke interesse
Het CBS verricht jaarlijks 600 onderzoeken op allerlei terreinen van de samenleving. Voor het uitvoeren ervan is het statistiekbureau voortdurend op zoek naar nieuw personeel op wo- en hbo-niveau. Een vereiste is een brede maatschappelijke interesse. Die is van belang omdat het CBS midden in de samenleving staat en flink investeert in zijn relaties met overheden, kennisinstellingen, bedrijven, etc. De onderzoekers Sylvia Bleker en Bart Wezeman zijn daar nauw bij betrokken en vertellen over hun ervaringen.
Sylvia Bleker studeerde economie aan de Universiteit van Amsterdam en het University College in Londen. Daarna ging zij aan de slag als consultant bij een economisch adviesbureau. ’Daar deed ik onderzoek voor verschillende overheidsorganisaties en werkte ik veel met CBS-microdata. Dat vond ik erg interessant en dat was voor mij de aanleiding om bij het CBS te willen werken.’ Ze solliciteerde op de functie

van statistisch onderzoeker/projectleider bij het team rechtsbescherming en veiligheid en werd binnen een week aangenomen. Ze begon in februari 2021.
MIGRATIE
Bij het team rechtsbescherming en veiligheid hield Bleker zich bezig met het maken van statistieken over asiel en migratie voor het Europese statistiekbureau Eurostat. ‘Die statistieken zijn
in de afgelopen jaren flink uitgebreid. Op dit moment levert het CBS jaarlijks in totaal ongeveer 150 verschillende tabellen hierover. Het was mijn taak binnen het CBS om de informatie voor Eurostat uit te vragen en de contacten te onderhouden met de dataleveranciers, zoals bijvoorbeeld de IND en Directie Regie Migratieketen van het ministerie van Justitie en Veiligheid’.
LOOPBAANONTWIKKELING
Dat bij het CBS volop ruimte is voor loopbaanontwikkeling van medewerkers bleek al snel. ‘In oktober 2022 ben ik in een nieuwe functie begonnen als senior onderzoeker en programmamanager Natuurlijk Kapitaalrekeningen. Daar kwam ik terecht doordat mijn vorige manager mij vroeg of ik interesse had om door te groeien naar een projectleidersfunctie. Hij liet me een aantal interne vacatures zien waarvan hij dacht dat ze bij mij zouden passen. De functie waarvoor ik gekozen heb, sprak mij zeer aan. Het onderwerp sluit namelijk goed aan bij mijn studie
ADVERTORIAL 8
TEKST MIRIAM VAN DER SANGEN FOTO SJOERD VAN DER HUCHT
economie. Daarnaast kan ik bijdragen aan het inzichtelijk maken van de cijfers rondom het klimaatprobleem.’
NATUUR
De Natuurlijk Kapitaalrekeningen gaan over de natuur in Nederland en hoe we daar gebruik van maken. Bleker: ‘Ze vormen een aanvulling op de nationale rekeningen, waaruit het Bruto Binnenlands Product (BBP) wordt berekend. In de nationale rekeningen en het BBP worden alleen economische factoren meegenomen, zoals kapitaal en werknemerssalarissen. Er zijn echter veel meer zaken die waarde toevoegen aan ons leven, zoals de recreatiewaarde van een bos of luchtfiltratie door de bomen. De Natuurlijk Kapitaalrekeningen brengen deze zaken in beeld als aanvulling op de bestaande economische nationale rekeningen.’
TALENTENBANK
Bart Wezeman begon zijn loopbaan bij het CBS in 2019. Na zijn studie econometrie aan de Rijksuniversiteit Groningen volgde een veelzijdige carrière, van statisticus bij KPN tot marketingmanager bij een wijnhandel. Ook het onderwijs kwam voorbij: hij gaf acht jaar les en vervulde diverse managementfuncties. ‘Maar ik miste de cijfers en besloot mijn hart te volgen.

Ik stuurde een open sollicitatie naar het CBS en kwam in de talentenbank terecht. Kort daarna werd ik gebeld met de vraag of ik projectleider bij het team Regio en Ruimte wilde worden. Na een goed gesprek van beide kanten was de beslissing snel genomen.’
KERNCIJFERS WIJKEN EN BUURTEN
Bij het team Regio en Ruimte werken twintig medewerkers - vaak met een geografische achtergrond en kennis van complexe Geografische Informatie Systemen (GIS) - aan regionale en ruimtelijke informatie op allerlei gebieden. Wezeman: ‘De kerncijfers over wijken en buurten zijn een belangrijk onderdeel. Deze regionale cijfers verschaffen inzicht in onder andere demografische en sociaaleconomische onderwerpen, bijvoorbeeld op het gebied van bevolking, wonen, energie, inkomen, sociale zekerheid en voorzieningen.’
BELEID
met de gemeenten. Het is voor ons van groot belang te weten aan welke cijfers zij behoefte hebben en hoe wij die goed vindbaar en toegankelijk kunnen maken. Daartoe hebben wij ook veel overleg met de Vereniging voor Statistiek en Onderzoek (VSO) die gemeentelijke en provinciale organisaties met elkaar verbindt op het gebied van regionaal onderzoek.’

HYBRIDE WERKEN
HENRI FAASDREEF 312
2492 JP DEN HAAG
TEL: (070) 337 38 00
CBS-WEG 11
6412 EX HEERLEN
TEL: (045) 570 60 00

WERKEN BIJ HET CBS!
BEN JIJ ER KLAAR VOOR?
WWW.WERKENBIJHETCBS.NL
De informatie die het team van Wezeman samenstelt, is van groot belang voor de 342 gemeenten in Nederland. ‘Op basis daarvan maken zij beleid. Wij hebben in de afgelopen jaren flink geïnvesteerd in onze relatie
Nadat Wezeman ruim drie jaar projectleider bij het team Regio en Ruimte was, kon hij met ingang van 1 april 2022 een mooie nieuwe stap in zijn carrière bij het CBS maken. Hij werd benoemd tot hoofd van dit team. ‘Drie dagen per week werk ik nu op het CBS in Den Haag, de overige dagen werk ik vanuit huis in Kampen. Dat is het hybride werken: deels vanuit kantoor, deels vanuit huis. Bepaalde werkzaamheden zijn prima vanuit huis te doen, ander werk doe je makkelijker op kantoor doordat je dan mensen fysiek spreekt en zaken in de wandelgangen kunt regelen. Dat geeft veel energie. Dat is ook wat ik wil overbrengen aan de mensen in mijn team, zodat ze met plezier hun werk kunnen doen.’
9 CAREER SPECIAL 01/2023
FEA TUR ED!
Scientific career
Are you thinking about obtaining a PhD? It could be a great option! There are several things to consider. You have to make sure that you love the topic you are going to work on, you have to make sure that you and your supervisor find a good way to cooperate, and you must be willing to learn a lot of new things and be able to deal with the unexpected. Contrary to what is often said, a PhD is more about personal development and getting to know yourself, than about the content of your topic. Although that is important as well of course. To find out more, talk to other PhD-students, they can share their first-hand experiences. Getting your PhD can be very rewarding, but it can also be equally tough, in the Netherlands less than 15% of all PhD students finish their thesis within the required time. Within 5 years, half of the PhD- students has finished. What is the main reason for this? Most PhD students are ambitious and perfectionists. Nothing wrong with that, but for finishing on time, you also need to learn to ask for feedback and reach out to ask questions. It is important that you learn to focus on the process. If you handle the process well, you will have an exciting journey, being at the frontier of science.
 Arjenne Louter, the Dutch PhD Coach
Arjenne Louter, the Dutch PhD Coach
GOOD TO KNOW
Dream
Helping early career researchers connect and collaborate is one of the goals of Delft Young Academy, says Board member Angelo Accardo. ‘At TU Delft, we have the Delft Technology Fellowships for exceptionally talented female researchers. One of my personal dreams is to have something along the same lines in the future for people with visual, hearing or motor disabilities to be really inclusive. It will take time but this is one of the topics we are working on.’
FACT
115 EXCELLENT SCIENTISTS HAVE RECEIVED A SPINOZA OR STEVIN PREMIUM, THE HIGHEST RECOGNITION FOR SCIENTIFIC RESEARCH IN THE NETHERLANDS, SINCE 1995. THIS YEAR, THE AWARDS WERE PRESENTED BY MINISTER ROBBERT DIJKGRAAF (OCW), WHO HIMSELF RECEIVED A SPINOZA PREMIUM IN 2003.

FYI 10
Career Café’s
You may often have heard that networking is the most important way to get a job. Did you know we offer online round table meetings with our UT alumni, called Career Café’s? Double win! A chance to build your own network as well as to learn from experiences of our UT graduates, for example about how they got their first job or what challenges they were facing.
Check: https://www.utwente.nl/en/ces/ career-services/career-cafe/
FACT
LIFELONG LEARNING IS POPULAR WITH WAGENINGEN ALUMNI. GRADUATION DOES NOT SIGNAL THE END OF THEIR DEVELOPMENT, AS IS CLEAR FROM THE FIVE-YEARLY CAREER MONITOR. THE SURVEY SHOWED THAT NEARLY ALL ALUMNI (98 PER CENT) CONTINUE LEARNING AFTER GRADUATION. ABOUT THREE QUARTERS OF THE ALUMNI HAVE FOLLOWED COURSES OR TRAINING FOR THEIR PROFESSIONAL DEVELOPMENT IN THE PAST THREE YEARS.
Entrepreneurial experience to TU/e
Students and researchers with plans for a start-up excel in enthusiasm and technical know-how, but lack entrepreneurial experience and a business network.

Four so-called Entrepreneurs-in-Residence (EIRs) have therefore been installed at the TU/e: highly experienced entrepreneurs who will spend one day a week coaching TU/e graduates who want to bring their invention to the market. Other TU/e policies that stimulate and regulate entrepreneurship are also being developed. New is the possibility of unpaid leave for permanently employed scientists who want to get a spin-off off the ground.

SILVIA LENAERTS, WHO AT TU/E HAS BECOME THE FIRST FEMALE RECTOR EVER AT A DUTCH TECHNICAL UNIVERSITY
‘Throughout my career I’ve often been the first or only woman. And now it’s the same again’
TIP 11 CAREER SPECIAL 01/2023
GOOD TO KNOW
QUOTE
4TU.SCHOOL FOR TECHNOLOGICAL DESIGN, STAN ACKERMANS INSTITUTE
EngD: continuing your studies while putting what you learn into practice
After completing your master’s, are you keen to gain some practical experience while continuing to study? You can do just that during a twoyear EngD programme at the 4TU.School for Technological Design, Stan Ackermans Institute (4TU.SAI). The EngD (formerly known as the PDEng) offers lots of advantages, according to chemical engineer Job Nijhuis.
The 4TU.School for Technological Design, Stan Ackermans Institute offers around 20 educational programmes related to technological design at the technical universities in Delft, Eindhoven, Twente and Wageningen. Each programme leads to an Engineering Doctorate (EngD) qualification. Whereas the more familiar PhD entails spending four years doing research, a two-year EngD is focused on the direct application of knowledge.
PROCESS DESIGN PROGRAMME
Job Nijhuis did his bachelor and master degrees in Chemical Engineering at TU Eindhoven, with a focus on chemical process technology. He completed his studies in December 2020, but he was keen to continue learning. ‘I was still interested in a number of subjects that I hadn’t had room for in my master, but I regarded a PhD as being too theoretical. On the TUe website, I noticed this process design programme that’s much more focused on applying your knowledge in practice.’
The EngD is a two-year programme. In his first year, Job studied around 30 different advanced subjects by focusing very intensively on one subject per week. ‘Some of those 30 subjects weren’t perfectly aligned with my interests,
and you don’t become an expert in them, of course, but it was a good way to gain exposure to many different aspects of potential career opportunities.’
TWO-YEAR PROGRAMME
Now in his second year, he is working on a design project related to energy savings on behalf of a large company. ‘The project is a combination of saving energy in the short term by identifying the ‘low-hanging fruit’ on the one hand, and a research question on the other: how can this factory benefit from heat pumps? How can we design a circular energy network within the factory so that the facility could become gas-free, for example? I’m tasked with analysing the water and energy flows in the factory and exploring how a heat pump could be integrated into the process.
VISIT THE WEBSITE: WWW.4TU.NL/SAI
12
ADVERTORIAL
TO KNOW MORE ABOUT ENGD PROGRAMMES?
KEEN
TEXT AND PHOTO LEO KOOMEN
It’s not only super interesting but also useful, because it’s an urgent challenge. That’s precisely what you do during an EngD: tackle more complex issues and design solutions for them.’
BENEFITS
‘In my view, an EngD offers various benefits. I’m expanding my knowledge in my chosen domain, it makes it easier to gain relevant work experience, and I still have lots of opportunities to do other things outside of my work. Besides being an ambassador for the EngD, I’m also chair of Atmos which is the association for EngD trainees across all nine EngD tracks. It’s not all hard work and no play. We also organise fun activities.’
Another benefit is the personal guidance. In addition to the supervisor from within the company where I work, I also have two supervisors at the university. One of them is focused on my project itself, and the other helps me to develop my skills in presenting, giving feedback and writing reports, for example. So you receive all kinds of support to prepare you for the next step, and I really appreciate that. So, if you still want to continue working on your own development, if you’re keen to explore all the possible options and if you’re not yet ready to commit to an employer, then an EngD is an ideal opportunity.’
REASONS TO APPLY
Does the Engineering Doctorate traineeship appeal to you and are you interested in becoming a technological designer? At 4TU.SAI we are always on the lookout for talented engineers with a master of science degree in a technical subject and who are keen to further develop their design skills. We currently have various openings in Delft, Eindhoven, Twente and Wageningen.



13 CAREER SPECIAL 01/2023
LIVE YOUR AMBITION
“Ik leerde TAUW kennen tijdens de Sustainable Motion bedrijvendag en had een gesprek met een collega uit Team circulaire economie. Hij vertelde me dat er op dat moment een vacature openstond en moedigde me aan om te solliciteren. Dit heb ik gedaan en ik werk nu al bijna twee jaar met plezier hier.”
- Joanne van ‘t Zelfde - Junior Adviseur Circulaire economie
Binnen TAUW houdt Joanne zich bezig met vraagstukken op het gebied van circulaire economie, voornamelijk gericht op grondstofstromen. Haar projecten zijn zowel voor overheidsopdrachtgevers als industriële klanten.
"Ik vind het leuk om beide soorten klanten te hebben, omdat dit verschillende vragen en uitdagingen met zich meebrengt," zegt ze. Joanne vindt haar werk bij TAUW erg leuk omdat haar projecten erg divers zijn, wat haar werk erg afwisselend maakt.

Ze vertelt enthousiast over een project waarin ze onderzoek heeft gedaan naar de circulariteit van gestoffeerde meubels, waar ze interviews heeft afgenomen met meubelmakers en vuilnismannen om circulariteit te onderzoeken. Daarnaast heeft Joanne de ruimte om naast haar projecten ook innovatieprojecten op te zetten. Momenteel doet ze onderzoek naar een digitaal materialenpaspoort waarin men een beeld krijgt van de kwalitatieve en kwantitatieve eigenschappen van een materiaal of product.
Joanne werkt nu al twee jaar bij TAUW en ze heeft het nog steeds erg naar haar zin.
“Ik vind de informele en open sfeer bij TAUW erg prettig. Iedereen is bereid om te helpen en enthousiast om dingen uit te leggen,” vertelt ze. Verder vindt Joanne het leuk dat duurzaamheid niet alleen binnen de circulaire economie, maar ook in de rest van de organisatie verweven is bij TAUW.
JOIN US AT TAUW WERKENBIJTAUW.NL
Proud of company philosophy
Student Industrial Design
Engineering
(IDE)
Daniel Hagmeijer of TU Delft took a statics exam in 2004 at the faculty of Architecture and the Built Environment, because information was spread that the exam assessment is more lenient there. This did not only bring him a pass, at that occasion he also met architecture student Leonie. Since 2012, they live together in Leonie’s country of birth Indonesia, together with their son of eight and daughter of six. He is Chief Marketing Officer at The Body Shop Indonesia.
In Jakarta, Daniel started at digital marketing company Mirum and he worked together with companies like Samsung, Unilever and Coca-Cola. He went through the entire marketing side: UX, marketing, market research, advertising and so on. ‘In the end, I was

running the company’, he says. After he led the merger of Mirum with Wunderman Thomson, he transferred to The Body Shop Indonesia. There as well, he has a broad portfolio. ‘I am responsible for marketing and communication, the brand policy, web and app design, media purchasing, the whole shebang.’ He does this with a team of about fifty employees. He traces his career success partly to his education. ‘At IDE you learn about things like consumer psychology, production methods and doing research. You become a generalist and you can start a conversation about subjects you are not and expert at’, he says.
BIOBRIDGES
He is proud of the company philosophy at his current employer: to fight for a fairer, more beautiful world. ‘Many companies express such a
message, but don’t really do much with it. The Body Shop does, that was the reason for my transfer.’ For example, last year the company campaigned to put a new law against sexual abuse, violence and marital rape back on the political agenda and eventually to get this law through parliament.
‘I’m glad I was able to play a part in that. We also collect money for building biobridges for endangered orangutans and the company is emphatically working on its own carbon footprint.’
PROGRESS
Over the last ten years, he has witnessed the company’s technological progress. ‘Indonesia has caught up with Western Europe in that regard’, he says. ‘A former classmate of mine works in the UX department of a large German company. Three years ago they sent a
team to Indonesia to see how we do it here’.
According to Daniel, Indonesia is a colourful country. ‘The Netherlands does have many shades of grey when you look at how people live. In Indonesia, people adapt very easily to circumstances, they are resourceful’, he says. A good example is the inventiveness of the many street vendors in Jakarta who turn every tree or piece of street furniture into a display. There is always something to do, even in the middle of the night. Appointments can be made spontaneously, without difficult agendas.’ One disadvantage is the air quality. ‘Cycling is not possible, you immediately find yourself in smog. Recently we arrived at Schiphol. ‘Such fresh air’, my son seriously reacted despite the kerosene smell.’
TU DELFT
DANIEL HAGMEIJER
A ALUMNUS TEXT AGAATH DIEMEL PHOTO OWN PICTURE #1 15 CAREER SPECIAL 01/2023
CMO AT THE BODY SHOP INDONESIA
GOOD TO KNOW
PhD Coach FEA TUR ED!
Arjenne started her career as a teacher in academic skills at a university, was a senior communication advisor at a Ministry, a senior trainer and consultant at a big consultancy firm and in 2002 she started her own company, occupying herself with teaching and research. Since 2008 her sole mission is to support PhD students to finish their thesis successfully, healthily and on time. By using a combination of all the skills she learned in previous jobs, and her skills as a mediator and coach she has been very successful in supporting PhD students. Her focus is the process of a PhD, because if the process works, the content will follow!
4 D’s
Studying means gaining new knowledge and skills but also learning to critically review existing theories and substantiate your outcomes. In other words: the correct scientific attitude. But how does one acquire this attitude? WUR offers a new course: Doubt, Dilemmas, Discourse and Dogma in Science.

The four key ingredients in the course are the D’s, says course coordinator Kan Kammenga. Doubt is the foundation of scientific research. ‘Doubt other people’s publications and research, but your own research also.’ Dilemmas: research is all about choices and the dilemmas therein. What do you do when you face a difficult choice or when you disagree with your thesis supervisor or colleagues? The third D stands for discourse. As a scientist, you are always involved in a discourse about your research and the theories and concepts on which it is based. Here, the media have a critical role because, as a scientist, you are not only discussing with fellow researchers but with the world at large. ‘We also teach about framing because there is always a possibility that the media states something about your research that makes you think: But, that was totally not what I meant!’ Kammenga says. ‘What will you do?’ And, finally, there is the D for dogma. This relates to becoming aware of dominant dogmas: that which is widely accepted and which we are expected to adhere to without asking critical question.
(Tekst Maurice Schoo Resource)
Find more information on www.thedutchphdcoach. com or on www.louterpromoveren.nl.
Application guide
Finding a job or an internship can be challenging. Student Career Services of Wageningen University & Research is there to help you. They provide elaborate guides on the most important aspects of an application, such as a making a CV, writing a motivation letter, setting up your LinkedIn profile, preparing for a job interview, preparing an elevator pitch, negotiating labour conditions and networking.
Check for more info:
Application guides - WUR
FYI
16
TIP
FACT
93% OF WUR ALUMNI FOUND PAID EMPLOYMENT OF MORE THAN 12 HOURS
A WEEK. FOR ALL DUTCH UNIVERSITIES
THAT PARTICIPATED 96% FOUND PAID EMPLOYMENT. THE AVERAGE TIME
BETWEEN GRADUATION AND THE FIRST PAID EMPLOYMENT IS 3,4 MONTHS FOR WAGENINGEN ALUMNI. FOR ALL DUTCH UNIVERSITIES THAT PARTICIPATED THE AVERAGE ‘SEARCH TIME’ IS 3,1 MONTHS. 34% OF THE WUR ALUMNI WITH PAID EMPLOYMENT ARE HAVING A PERMANENT CONTRACT. 26% OF THE WU ALUMNI IS WORKING ABROAD.

JEANNE PARMENTIER FROM THE PERVASIVE SYSTEMS GROUP AT THE UNIVERSITY OF TWENTE AND THE UTRECHT UNIVERSITY FACULTY OF VETERINARY MEDICINE.

GOOD TO KNOW
Going Dutch
As an international, building a career in the Netherlands is not always as easy as it seems. It requires developing a feel for Dutch culture, knowing more about Dutch organisational cultures and businesses, as well as sufficient Dutch language skills. For those international students who want to start their career in the Netherlands the UT offers a Minor “Going Dutch, kick start your Dutch Work-Life”. For students with less time, UT Career Services team offers specific 2- hour workshops like Finding a job in the Netherlands or workshops on how to use LinkedIn to orientate on the job market.
FACT
STAATSEXAMEN NT2 E-COACH
YVONNE VAN DEURSEN - BAKX STARTED HER CAREER AS DUTCH NT2 TEACHER AT THE TU/E. SHE REGULARLY RECEIVED QUESTIONS FROM STUDENTS REGARDING THE NATIONAL EXAMINATION OF DUTCH AS A SECOND LANGUAGE (STAATSEXAMENS NT2). SINCE JANUARY 2021 IT IS HER MISSION TO HELP HIGHLY SKILLED INTERNATIONALS PASS THE EXAMS. THE NATIONAL AVERAGE SUCCESS RATE IS ONLY 62 PERCENT.
WITH THIS DIPLOMA STUDENTS CAN OFFICIALLY PROVE THE LEVEL THEY HAVE REACHED AND MENTION IT ON THEIR CV. AFTER FIVE YEARS OF LIVING IN THE COUNTRY, INTERNATIONALS CAN APPLY FOR DUTCH CITIZENSHIP
WITH THE B1 DIPLOMA. PROGRAMMA I TESTS AT B1 LEVEL AND PROGRAMMA II TESTS AT B2 LEVEL FOR ALL FOUR SKILLS ACCORDING TO THE COMMON EUROPEAN FRAMEWORK OF REFERENCE FOR LANGUAGES (CEFR).

QUOTE
‘If anyone is considering to do a PhD, I’d advise them to get to know their group before they start’
17 CAREER SPECIAL 01/2023
Technische studie afgerond?
Traineeship Berenschot!
Waardevolle praktijkervaring
Na zijn studie Chemical Engineering aan Rijksuniversiteit Groningen koos Ernst de Vries voor een traineeship bij Berenschot. Momenteel is Ernst betrokken bij verbeteringsprojecten in de maakindustrie, waar hij operationele uitdagingen benadert vanuit de filosofie van Operational Excellence. “Zo heb ik bij het herontwerpen van de productiehal voor een klant in de metaalbewerkingsindustrie de meest voorkomende productroutes geanalyseerd om tot een optimale lay-out te komen.” Direct meedraaien in opdrachten is voor Ernst een belangrijk pluspunt van het traineeship bij Berenschot. “Al in mijn derde week had ik mijn eerste klantafspraak, wat mij waardevolle praktijkervaring heeft opgeleverd. Het contact met ervaren adviseurs en mentoren is daarbij heel waardevol, zij ondersteunen en begeleiden mij in mijn professionele groei.”
Netwerk opbouwen
Ook Joran van den Berg wilde zich na het afronden van zijn studie Technische Natuurkunde en Nanotechnology aan de Universiteit van Twente toespitsen op het adviesvak en alle bijbehorende soft skills. Zijn technische achtergrondkennis komt goed van pas in projecten, zoals het opzetten en begeleiden van technische innovatieprojecten en het zoeken naar financieringsmogelijkheden.
Joran: “Je bent constant bezig jezelf te verbeteren, de focus ligt niet alleen op het uitvoeren van opdrachten. Daardoor zet je snel stappen in het adviesvak. Elke traineedag wordt afgesloten met een borrel en we ondernemen ook veel activiteiten buiten het werk.”
Beeld van je eigen toekomst
Goede leermogelijkheden en de vrijheid in projecten en planning waren voor Noa Zuijderwijk, die Air Transport Operations studeerde aan de TU Delft, de voornaamste redenen om te kiezen voor een traineeship bij Berenschot. Op dit moment houdt zij zich vooral bezig met het maken van dashboards in PowerBI. Haar technische achtergrond biedt belangrijke voordelen. “Bij klanten in de technische sector zit je makkelijker op één lijn, omdat je de inhoud ook goed begrijpt.”
In Noa’s ogen slaat het traineeship een fijne brug tussen de studie en het werkende leven. “Je draait vier dagen mee in het advieswerk, maar hebt daarnaast tijd om vaardigheden aan te leren en je werk, aanpak en doelen te bespreken.”
Ruime mogelijkheden
Het Berenschot consulting traineeship duurt een jaar en samen met zo’n vijftien medetrainees ontwikkel je je van startende professional tot ware consultant. Daarbij staat elke vrijdag volledig in het teken van jouw persoonlijke groei.

Over Berenschot
Berenschot is een zelfstandig, onafhankelijk, Nederlands organisatieadviesbureau met meer dan 400 medewerkers. Wil jij ook meewerken aan een vooruitstrevende samenleving? Bekijk onze vacatures op www.berenschot.nl/vacatures
Berenschot
I Bored at work? That doesn’t have to be a bad thing
For many managers, employees who get bored during working hours are a nightmare. But according to UT researcher Caroline Fischer, it doesn’t have to be a problem. ‘Boredom is a functional emotion.’
Preparing lectures, writing research proposals, doing research, answering emails and grading exams: Caroline Fischer herself has little or no need to be bored as an assistant professor in Public Administration at the UT. In fact, she regularly longs for a free hour to daydream. It triggered Fischer and Carina Schott (assistant professor at the Utrecht University) to conduct a literature study into workplace boredom. As it turned out, boredom is mainly seen as something negative. ‘We started our research with management literature. In these studies, workplace boredom is seen as unproductive and not valuable. Managers even make up all kinds of tasks or jobs to avoid it.’ And this is bound to increase, the assistant professor expects. ‘Due to digitization and robotisation, more and more human tasks will be reduced to monitoring, where boredom is likely to occur.’
NEW INSIGHTS
To get a different perspective, Fischer and Schott decided to use psychological literature in addition to the management studies. ‘That provided us with a very different picture. Within positive psychology, boredom is seen as a functional emotion, stressing a positive aspect in this unpleasant state. When

people are bored, they instinctively look for different things to do. It is a coping mechanism, because boredom is actually not a pleasant feeling. This search for distraction does not have to be negative. It might as well lead to new insights and directions in work.’

Organisations can help employees to discover these ‘bright sides’ of boredom. For this, autonomy is key, argues Fischer. ‘Organisations should deal with boredom in a more relaxed way. It is not the end of the world when employees get bored for a while.’ Still, it is important to guide the search. ‘It is of little use when an employee starts listening to music to avoid boredom. Therefore, a manager should provide alternatives during moments of boredom, such as online training and courses. Promoting a chat in the hallway with colleagues can also lead to positive outcomes: people exchange ideas and widen their network. In this way, it facilitates productive coping behaviours.’
For their research, Fischer and Schott did a comprehensive literature review. A follow-up would be an empirical study on workplace boredom. ‘Think of a fire brigade, where employees are waiting in standby mode for the next call. We know from studies that employees develop negative coping mechanisms in these situations, such as excessive snacking and aggression. The question is whether this is due to boredom. We would like to study that in the future.’
19 INTERVIEW TEXT JELLE POSTHUMA PHOTO SHUTTERSTOCK & OWN PICTURE CAREER SPECIAL 01/2023
CAROLINE FISCHER ASSISTANT PROFESSOR
3 ways in which Europe’s green recovery will create opportunities for young engineers

The announced European recovery and resilience funds are coming into play and are being underlined in the recent announced REPowerEU initiative. Working on the energy transition and securing access to energy are going hand in hand. These developments all require a well educated workforce and provide opportunities for young engineers.
The following pieces are falling into place, highlighting the pivotal role of sustainable energy (and the need for well-trained energy engineers) during the post-pandemic recovery and beyond:
The European Green Deal
During the pandemic we saw a temporary positive impact on some of the measurements of for example CO2 emissions or use of fossil fuels. When we return to “business as usual”, we must ensure that the economic recovery doesn’t undo all the previous hard work put towards climate goals.
The European Parliament wants Europe’s future to be green and sustainable, so
members have resolved to use the European Green Deal as the cornerstone of the EU’s recovery. They want to kickstart the economy sustainably and create jobs to protect key industrial sectors while pursuing an ecological transition. Thus, sustainable energy will play an integral part in this green recovery.
The energy storage industry alone will take centre stage. The continent expects to increase its production capability 20-fold in the next seven years. This could result in 100,000 new jobs every year. This growth will be delivered by a new wave of experts that need to be trained in the skills of tomorrow. This is where EIT InnoEnergy’s role in training top talent for the energy transition comes in.
Having already introduced a Master’s in Energy Storage, EIT InnoEnergy launched in 2020 its plan to build a Battery Academy to train and upskill 16,000 European workers in this value chain by 2025.
The Green Recovery Alliance
The EU Parliament, together with big names from politics, industry, the European Trade Union, and the private sector – including EIT InnoEnergy’s CEO Diego Pavia – have signed the Green Recovery Alliance that builds upon the European Green Deal. This new alliance places sustainable energy at the heart of Europe’s economic recovery, creating countless opportunities in this sector for years to come, and thus jobs for trained young professionals. Dr Frank Gielen, Education Director of EIT InnoEnergy, shares:
“Turning Europe into a climate-neutral continent in three decades was already a daunting task. We will need to fill hundreds of thousands of new jobs and roles by 2030 to meet energy demands and reduce emission
targets. By 2050, it will be millions. This new alliance simply reinforces our resolve to utilise sustainable energy to recover post-pandemic.”
An urgent need for trained energy engineers Signatories of the new alliance are committed to investing in solutions that are aligned with climate commitments while reviving the economy. With sustainable energy innovation at the very centre of the agenda of EU governments and industry – this sector is ramping up, creating an urgent need for trained energy engineers. EIT InnoEnergy Master School will continue with its mission to prepare the next generation of energy engineers via innovation and entrepreneurship
Shape your future in sustainable energy

Would you like to combine top knowledge in energy engineering with training in entrepreneurship and access to the most thriving start-ups in the energy sector in Europe?


training, which now becomes even more vital.
As Dr Gielen explains, “Right now, we are creating a scalable, networked learning infrastructure that will implement specialised learning enablers and ‘Green Deal Digital Learning Spaces’ tailored specifically to meet the priorities areas of the Green Deal plan.”
With these essential elements all coming together to ensure a smooth and prosperous green recovery as well as being more energy independent in Europe, it’s the perfect time to find out what part you can play in this exciting process!

Our unique European Master’s programmes address the most exciting and important areas in sustainable energy and energy engineering. You will study in two different countries and obtain a dual degree from our partner universities. Interested in renewable energy, smart cities, or clean fossil fuels? Want to be an expert in smart grids, or gain a broader overview of current and future energy technologies? We have the programme for you.
Interested? Join us!
Email: innoenergy@studyenquiry.com
Phone: +44 3331 500488
WhatsApp: +44 7407 303554
www.innoenergy.com/
masterschool
14 94% 10
5 Top Technical Universities Employment rate six months after graduation Most dynamic countries to study in Europe Graduates making an impact in the energy transition Entrepreneurs in Forbes 30 under 30
1200+
‘No, thank you. I don’t have any other questions.’ If a job interview ends and these are the words of the applicant rather than the employer, this is an example of the new approach to job applications. After all, there is plenty of work around. But, according to Petro Walters, it’s the wrong approach. ‘The aim is to get a job at a company that suits you. In the long term, enjoyment in your work is what matters most.’
The new approach to job applications: ask questions
Walters is co-owner of the KERN Engineers recruitment agency from The Hague, which links up highly qualified engineers with companies. Part of his work involves preparing graduates for job interviews. His most important advice?
‘Ask questions! Your application only really starts when you hear the words: do you have any questions? Of course you have questions! You actually have lots. They are mainly about the content of the work. This may lie at the heart of the new approach to job applications. In the past, things were much more formal and you were happy even to be offered a job.’

PREPARATION
It may sound like a cliché, but it applies to any job application: effective preparation is what matters most. ‘You should ask yourself questions like: what kind of work do I actually want? What’s the nature of the work? Why am I looking for this work? If – to take an example – you want to work for Shell, then you shouldn’t just ask yourself whether you’re good enough for Shell – or possibly even too good – but you also need to ask yourself whether you’re really cut out to be a Shell person.’
According to Walters, something else you also need to think about as an applicant is which tech companies you want to work for. ‘Do plenty of research so that you know what is being asked. Does that suit me and my ambitions?’ And: ‘Go and take a look for yourself. What departments does the company
For any job application: effective preparation is what matters most
TEXT PETER KOEHORST PHOTO OWN PICTURE INTERVIEW I 22
have? Which people work there? Always try to approach someone who works there. You can do that via LinkedIn, for example.’ According to the recruiter, a job interview can never happen totally online. ‘You can only really get to know someone face-to-face.’
But has the power really shifted in favour of the applicant?
‘Job applicants certainly can’t make extreme demands. For example, if a company appoints several people with the same background, it can’t pay several different salaries. You need to communicate openly and honestly about that.’
‘Above all, the applicant needs to be inquisitive and ask lots of questions. That’s much more important than insisting on exceptional primary or secondary terms of employment. In the Netherlands, these tend to be generally good anyway.

What really matters is having a great job that you enjoy doing. What kind of management style can I expect? What kind of induction or onboarding processes can I expect? Who will I be working with? Will I be able to apply all my technical skills?’
PASSION AND AMBITION
Years ago, Walters had an excellent example of a successful match, when he was working for Royal IHC. A letter arrived from a German man. ‘At the job interview, a shy young man appeared before me’, explains Walters. ‘He sat down and said: finally I’m here! So I asked: what do you mean? When he was just twelve years old, he saw a trailing suction hopper dredger in the port of Hamburg and was hugely impressed. Years later, he took a study programme focusing on the dredging industry. He discovered that Royal IHC is the market leader in the world of dredging. He was really eager to work there. The man had been working towards this job interview for twelve years. That’s why he said: finally I’m here. There was only one possible conclusion: the job is yours. The passion and ambition were so obvious that I simply couldn’t refuse an applicant like that.’
FIVE TIPS FOR ALUMNI AND NEAR-GRADUATES FOR A PERFECT JOB APPLICATION:
1-MAKE SURE THAT YOU KNOW EXACTLY WHAT YOU WANT AND DON’T WANT.
2-MAKE SURE THAT YOU CAN ALWAYS GET A FEEL FOR THE ATMOSPHERE.
3-ENGAGE IN A PERSONAL CONVERSATION WITH YOUR FUTURE MANAGER.
4-MAKE SURE YOU NOT ONLY FIND OUT HOW YOU CAN ADD VALUE FOR THE COMPANY, BUT ALSO WHAT THE COMPANY CAN ADD FOR YOU.
5-DON’T BELIEVE IT IF A COMPANY SAYS THAT EVERYTHING IS POSSIBLE.
PETRO WALTERS HAS THREE QUESTIONS FOR JOB APPLICANTS TO WHICH THE ANSWER MUST BE ‘YES’. ‘IF THE ANSWER TO ANY OF THE QUESTIONS IS ‘NO’, DON’T EVEN THINK ABOUT IT.’
1- ARE THE DAY-TO-DAY ACTIVITIES GENERALLY ENJOYABLE?
2- DO I FIT INTO THE COMPANY CULTURE?
3- CAN I GET ALONG WITH MY IMMEDIATE MANAGER?
23
CAREER SPECIAL 01/2023
PETRO WALTERS CO-OWNER OF KERN ENGINEERS RECRUITMENT AGENCY
At the forefront in technology innovation for breeding crops

At KeyGene in Wageningen, Nathalie van Orsouw leads the Technology Development department with several teams working on innovative technologies using e.g. advanced DNA sequencing platforms and innovative genome editing in crops. ‘Our partners expect us to always be one step ahead,’ she says.
After studying Medical Biology in Amsterdam, Van Orsouw started her career in the USA, in the field of cancer genetics and aging, and graduated in 1998 on the development of a novel technology to identify genetic mutations that can cause cancer or aging. When she moved back to the Netherlands in 2002, she applied for a job at KeyGene. ‘This may seem like a massive career switch, but the technologies I worked on in the USA are equally applicable to plant genomes,’ she explains. Van Orsouw started as project leader and is currently the Vice President Technology Development. She never regretted her transfer: ‘Plant Biology continues to be a challenging and interesting field.’

SEQUENCING GENOMES TO IMPROVE CROPS
KeyGene’s partners are predominantly plant breeders in business and at institutes. ‘Knowledge of relevant genes and their expression helps our clients to develop plants with certain desired characteristics like resilience to drought or diseases,’ says Van Orsouw, who leads several teams that work on and with DNA isolation and genome sequencing, as well as genome editing, regeneration and digital phenotyping. ‘The innovation process is different

every time,’ she says. ‘For example, the process of isolating DNA differs for each type of plant. Furthermore, when we have identified a certain gene and are able to modify it in the desired way, we need to grow plants with the new characteristic, which is not always straightforward and requires a specific strategy for each type of crop.’
ALWAYS ONE STEP AHEAD
Work in the Technology Development department is therefore always innovative, and often rather complex. ‘Fortunately, we have very creative people in our teams, including recently graduated young talents,’ Van Orsouw says. ‘KeyGene also offers employees room and funding to explore new, outof-the-box ideas and to rapidly develop new skills and competences. This is great fun, and has strategic value: our partners expect us to always be one step ahead.’
Collaboration often gives the company early access to the latest technologies in sequencing. KeyGene has strong bonds both with universities and with companies that produce equipment for e.g. DNA technologies. Van Orsouw: ‘We work together closely with Oxford Nanopore Technologies, for example. We often have early access to new prototypes or software. We test the
equipment for them, and gain knowledge on how these innovations can be valuable for our strategic partners.’
DIRECTLY APPLICABLE
As Vice President, Van Orsouw is not only responsible for creating the optimal conditions for her staff to flourish. She is also part of the management team that develops long term strategies for KeyGene. ‘Again, collaboration is essential,’ she points out. ‘Innovations that are really capable to give breeding a boost, go beyond one’s own fields of expertise. For example, bioinformatics is essential to solve the complex issues the experts in my group are working on.’ Van Orsouw is proud of what KeyGene is able to achieve as a relatively small company, she says: ‘With ‘only’ 150 employees, we work on so many different projects, for and with a lot of different partners. This is only possible because we have such a valuable knowledge network, and our employees are able to collaborate quickly and efficiently. We are developing techniques that are directly applicable in the breeding process, which is very satisfying.’
ADVERTORIAL 24
TEXT BAUKE VERMAAS PHOTO KEYGENE
Automatic waste sorting bin
OBSTACLES AND ACCOLADES
Garby indeed seems to be working. It recognizes the ‘trash’, which it then moves into one of the four compartments based on the Dutch waste stream – organic, plastic, paper and residual. All within a few seconds. The functional prototype has brought PLAEX a fair share of success, including an array of prizes such as the Prototyping Award at UT Challenge 2020, CSU Innovation Award 2020 and making it to the Top 5 Ideas at Philips Innovation Awards 2022.
Throw your trash in and the bin will do the rest. Garby the Garbage Bin, as the young graduates call their waste sorting device, identifies the object and places it into the correct compartment. Recycling made easy. Or as, the company’s CEO Tyrell Pantophlet puts it: ‘It’s not complex, it’s PLAEX.’ The two founders came together in 2020 thanks to their joint passion for sustainability. ‘We want to promote sustainable transition’, says Pantophlet, graduate of Advanced Technology. ‘I’m really bothered by incorrect recycling. I was born in Saint Maarten, where we have a lot of problems with sustainability. There are landfills that are constantly burning, which I really hated. I want to contribute to a future where all waste is properly recycled. I want to create a better tomorrow, so that my kids don’t have to suffer.’
‘Recycling is a fascinating world’, adds Victor Okoro, PLAEX’s CSO who studied Psychology at the UT. ‘The more we look into it, the more we see that only a couple of changes can have drastic consequences. What we are doing can have an immense social and environmental impact. This is a great thing we are working on.’
From the beginning, the start-up aimed to provide services mainly to companies and businesses, as they produce more waste than households. ‘Unfortunately, we’ve learnt that the waste management market is not set up in our favour’, says Okoro. ‘At the moment, it is cheaper for companies to only recycle paper and put everything else into residual waste. The financial incentive to get a fully recycled stream was therefore too low and our invention was not useful for the market.’
As of 2023, this could all change. Thanks to new national rules, it will be more attractive for companies in the Netherlands to separate plastic, metal cans, drink cartons and glass waste. Even though, the journey has been far from easy, the alumni duo is most certainly not ready to quit. ‘We are close to starting a pilot with a large customer. We are ready to move from a prototyping phase to the revenue phase and actually make a change.’
AMBITIONS TO START YOUR OWN BUSINESS AS WELL? CHECK OUT THE POSSIBILITIES AT NOVEL-T.

START-UP TEXT MICHAELA NESVAROVA PHOTO RIKKERT HARINK S 25 #1 CAREER SPECIAL 01/2023
‘We have one world and we should keep it’, say Tyrell Pantophlet and Victor Okoro, co-founders of start-up PLAEX. The UT alumni developed a smart recycling bin which uses artificial intelligence to automatically sort waste. Its goal: contributing to a more sustainable future.
PLAEX
De makers van morgen
Deze Evokers maken de toekomst. Zij kozen voor een duurzame carrière waarin ze niet alleen aan zichzelf, maar ook aan de toekomst bouwen.
LE DOUX: Service Engineer en toekomstvisionair
‘Ik wil vooruit kijken. Verder dan de neus lang is. En zo zwakheden in data opsporen en ontleden.’ IT risico’s vóór zijn, dat is wat IT’er Simen Le Doux wil. Een slimme visie, die hij ook op zijn eigen carrière toepast. ‘Ik wil dat organisaties vérder kijken. Net zoals ik mezelf blijf uitdagen en ontwikkelen.’
Als Interim Professional bij Evoke gaat hij niet op één werkplek aan de slag om daar te blijven, maar bouwt hij een cv op met verschillende projecten. Zijn eerste rol: Remote Service Engineer bij Signify. ‘In de praktijk betekent dat: data bekijken en de meest voorkomende storingen uitleggen aan de interne afdeling en de klant. Een soort technisch tolk dus.’
Om dat te doen bij Signify was een bewuste keuze. ‘Een bedrijf moet zich bezighouden met de toekomst; CO2 neutraal zijn. Dat maakt Signify waar.
Alle onderdelen zijn herbruikbaar of recyclebaar. Die groene toekomstvisie is ook de reden dat ik koos voor Evoke.’

MERYEM YIGIT:
BIM Modelleur van duurzame huizen

Evoker Meryem is ‘a woman with a plan’. Uiteindelijk hoopt ze zich Junior Architect, gespecialiseerd in duurzaam bouwen, te noemen. En de eerste stappen in haar plan zijn hiervoor al gezet. Zo heeft ze onlangs haar vooropleiding in bouwkunde afgerond en is ze gestart als BIM Modelleur bij architectenbureau Quadrant, via Evoke. Daar bouwt ze met een team van drie collega REVIT Tekenaars aan verschillende ‘blokken’. ‘Huizenblokken. Bijvoorbeeld een reeks rijtjeshuizen naast elkaar in Oss. Daar ontwerpen we een complete wijk die duurzaam wordt ingericht. Denk aan warmtepompen en zonnepanelen voor energiebesparing op de woningen, maar ook aan de omgeving. Zo tekenen we plek in voor vogelhuisjes, vleermuishuisjes en bewuste groenvoorziening: zoals een vijver voor natuurlijke waterafvoer, in plaats van rechtstreeks naar het riool. Collega’s bedenken die concepten en wij werken alles uit in detail tekeningen.’

JOEY NABBEN:
Engineer Vehicle Installation E-trucks
Joey Nabben wist precies wat hij wilde. Werken bij DAF Trucks, net als zijn vader. ‘Ik had al vaker contact gehad met Evoke, nu was er een vacature bij DAF… Ik zei meteen ja!’ Als Engineer Vehicle Installation stuurt hij enkele mensen aan en is hij zelf ook nog bezig met het maken van 2D- en 3D CAD-tekeningen voor de e-trucks van Eindhovense vrachtwagenfabrikant.
‘Een nieuwe elektrische truck komt eraan. Daar zijn we verschillende as configuraties voor aan het maken en ontwikkelen we nieuwe varianten. Zo zorg ik er bijvoorbeeld voor dat de high-voltage kabels van steuntjes worden voorzien. Daarbij moet je ook een krachtenanalyse maken, of de steun sterk genoeg is om de kabels te dragen. De elektriciteitskabels lopen bij de E-truck letterlijk door het hele voertuig heen, van voor naar achter. Daardoor heb ik met alle teams binnen DAF te maken.’

26
ADVERTORIAL
SIMEN
LEES
MEER OP EVOKESTAFFING.NL/MAKERS
WIL JIJ OOK WERKEN AAN DE TOEKOMST? VAN JEZELF EN VAN DE WERELD? KIJK OP EVOKESTAFFING.NL/TOEKOMST
THE PARADOX OF CHOICE
Picking a line of work in the past was simple – you just did what your father did, who did what his father did, and his father before him, and so on. If you were a woman, you didn’t get to choose; you were saddled with housework and children. If you were a man with unorthodox interests, you didn’t get to choose either; you did what was expected of you. It was an awful system, but undeniably simple.
Today, this antiquated practice would make me a manager of the Indian Railways. Or otherwise, a paper-pushing government official of similar stature. As luck would have it, I am instead a mechanical engineer turned automotive human factors researcher in the Netherlands. I am also, it could be said, something of a writer. Both these professions involve hunching like a gargoyle over a laptop and churning out content from behind the safety and solitude of a screen. And oddly, a part of me actually enjoys this arrangement! Yet I often find myself seeking out more social roles that put me in the public eye, be it serving on the PhD council, delivering speeches for the university, organizing employee events, or representing my research group at summer schools and conferences. And all this barely scratches the surface of my social “distractions”, as my professors like to put it.

What’s more, my favorite subject in school growing up was history, which it staunchly remains to this day. I wonder if both my parents being history majors has something to do with it. Either way, I now spend my free time admiring art and artifacts in museums. So, is it just me or has the world these days run off and gotten all confused about interests and careers? It’s the paradox of choice.
In a mere 10 months, my PhD will officially end, and perhaps also my stint the Delft journalistic platform Delta. I do not know yet what the future holds, but one thing is certain – I’ve always been passionate about not starving to death. Based on career events and chats over coffee with senior colleagues at TU Delft from different walks of life, I’ve narrowed it down to an evolving list of criteria that a job should ideally meet – future-proof, communicative, social, academic-ish, and scientific-ish. And upon reflection, some paths that spring to mind are science communication, AI prompt engineering, teaching, grant/policy/ethics advising, data stewardship, and product/business/community management.
Regarding a postdoc, I possess the skillset (eye-tracking in traffic situations, and perhaps in art and video games) but I wonder if I possess the temperament. As for being a journalist, I possess the temperament but not the formal qualifications. And about doing engineering/research in industry, I possess the qualifications but I wonder if I possess the drive. Oh well, at least I am driving hard at improving my Dutch before I graduate.
And until that day of reckoning comes, in quiet defiance of the past, I shall dip my fountain pen in the inkwell of hope, scribble words of motivation upon the pages of fate, and let fly my applications on the winds of fortune.
COLUMN C #1 27 CAREER SPECIAL 01/2023
Vishal Onkhar, PhD candidate working in the Cognitive Robotics department of TU Delft
Welcome to your global 4TU alumni network! A strong, tight and worldwide network of Dutch engineers. This network, consisting of alumni from TU Delft, Eindhoven University of Technology, Wageningen University and Research and the University of Twente, is represented in the most prestigious organisations within our different technical fields, but in many cases also in self-funded start-ups. The network, therefore, represents a significant source of skills, contacts, and advice.
Don’t forget about WUR!
Once a Wageninger, always a Wageninger! As a WUR graduate, you belong to a worldwide community of more than 60,000 alumni. The WUR community is the place to keep your knowledge up to date, get inspired by our research, and to meet other Wageningers. Check out www.wur.eu/alumni for all information on what we can do for you after graduation and make sure to update your contact details via www.wur.eu/changecontactinfo so we can stay in contact with each other.
UTwente Young Alumni Network

Young alumni face different challenges than someone whose career is further along. Therefore, young alumni under the age of 35 can join the UT Young Alumni Network (YAN). YAN organises readings, workshops, networking drinks and other activities. These activities are focused on personal and professional development, networking, company visits and, of course, having fun.
The UT Young Alumni Network: for and by young alumni. Join us! utwente.nl/yan or e-mail: alumni@utwente.nl

connected to TU Delft
Keep developing yourself! You can follow interesting online courses with a discount, get free access to scientific research at the library and expand your network at interesting (company) events. Check out the TU Delft Career Centre for one of their workshops, make use of the one-to-one coaching sessions and find interesting vacancies at the TU Delft Your Career Portal. Want to know more? Join the alumni portal www.TUDelftforLife.nl.
Welcome
FEA TUR
FYI TIP TIP
TO KNOW 28
Stay
ED!
GOOD
FACT
PLEASE REMEMBER THAT ALL ALUMNI ARE ALSO MEMBERS OF A MUCH LARGER NETWORK OF OVER 280,000 GRADUATES FROM THE FOUR DUTCH TECHNICAL UNIVERSITIES
WHICH CONNECTS YOU TO A RICH LEGACY OF INNOVATION AND EXCELLENCE. BE PROUD AND SHARE YOUR EXPERIENCES AT OUR INSTITUTIONS WITH OTHER PEOPLE. BESIDES
JOINT ACTIVITIES IN THE NETHERLANDS, THERE ARE ACTIVE ALUMNI COMMUNITIES IN AUSTRALIA, CANADA, FRANCE, GERMANY, THE NORDICS, SPAIN, SWITZERLAND AND THE USA. JOIN YOUR GLOBAL 4TU ALUMNI NETWORK!

Connect with TU/e alumni worldwide!


Stay connected with your fellow study mates and register on the TU/e Alumni Portal! Being a member of the Alumni Portal provides you a lot of advantages. You can meet other alumni, become a member of the Alumni Association or stay informed about the latest news at TU/e. Watch our inspiring videos on www.tue.nl/alumni and discover what the Alumni Portal can mean for you. Last but not least, join our Alumni events and get inspired! TU/e alumni - Connected for life!
QUOTE
‘Maintaining alumni connections post-graduation bolstered my career. My network provided swift access to diverse expertise across my professional ecosystem, from seed to growth light providers’
FYI 29 CAREER SPECIAL 01/2023
PAVLOS KALAITZOGLOU, VICE PRESIDENT OF SCIENCE AT INFARM, MSC PLANT SCIENCES (2010) AT WUR.
We are the leading global provider of advanced processing systems and services for the poultry, meat and fish industries. We are innovators and trailblazers. We bring together the best people, the most advanced technology, and cutting-edge machinery to deliver real change in the way food is processed and consumed.
Benefits of working at Marel include:
• A large, international company
• A technical, challenging environment
• Potential is recognized and cultivated
• Interesting development opportunities
• Enthusiastic and engaged employees

Find out more

For our people, It’s easy to stay driven when you do For our people, passion isn’t just a buzzword
It’s easy to stay driven when you do something important. Head to jobs.marel.com and see for yourself.
ADVERTORIAL
‘Vak octrooigemachtigde is een vrij beroep’
Octrooibureau Arnold & Siedsma is altijd op zoek naar mensen met een technische achtergrond. Hoewel het beroep octrooigemachtigde weinig bekendheid geniet, is het een interessante baan voor bètastudenten met alfa- en gammatalent.
Voor een eerste indruk is het goed om te weten dat een octrooigemachtigde in het Engels een ‘Patent Attorney’ wordt genoemd. ‘Octrooi’ is het Nederlandse woord voor patent (patent is eigenlijk geen Nederlands woord). Echter is een octrooigemachtigde wel anders dan een advocaat. Een octrooigemachtigde schrijft octrooien en probeert deze daarna verleend te krijgen bij de ‘octrooirechter’ van de European Patent Office bijvoorbeeld. Voordat we een octrooi schrijven, gaan we eerst langs bij de klant om te begrijpen wat de uitvinding is. We vragen van alles. Checken het waarom en of het ook anders kan. Daarna begint de niet-technische uitdaging; het vertalen van techniek naar taal. We bouwen een octrooi zo systematisch mogelijk op, van essentiële kenmerken naar details, en proberen het zo te verwoorden dat alle alternatieve mogelijkheden onder die verwoording vallen.

PUZZEL
Het is altijd een puzzel om te zorgen dat het octrooi alles omvat én nieuw en inventief is ten opzichte van wat er al bestaat. Tijdens de verdediging van het octrooi tegenover de octrooirechter werken alleen de sterkste argumenten. In het geval van bijvoorbeeld octrooi-inbreuk zijn we betrokken bij rechtszaken voor de civiele rechter. Voor dit beroep is een bètaopleiding nodig; het is zelfs wettelijk verplicht. Een octrooigemachtigde moet alle verschillende technische uitvindingen waar we dagelijks mee te maken krijgen goed kunnen begrijpen. De alfa aspecten zijn hierboven al toegelicht - octrooien zijn ook een talig gebeuren - en gamma zit in de juridische kant van dit beroep.
NIEUWE TAAL
Voor zowel de alfa- als gammakwaliteiten krijg je als octrooigemachtigde een Nederlandse en een internationale opleiding. Gedurende drie jaren, in ongeveer één dag per week, krijgen alle nieuwe octrooigemachtigden in opleiding uit Nederland en België samen les over het juridische stelsel en ook over het schrijven van octrooien, verdedigingen of aanvallen en het opstellen van een advies. Zo leer je een heel nieuwe taal.
ONBEKEND BEROEP
Het is niet gek dat weinig mensen het beroep kennen, aangezien maar 550 mensen in Nederland en België het beoefenen. Maar, voor de technische studenten die op zoek zijn naar meer dan sommetjes is het goed om te weten dat consultancy en PowerPointpresentaties niet de enige verbredende weg zijn. Dit vrije beroep biedt steeds nieuwe verdieping.
IRIS LAMBERT – TRAINEE OCTROOIGEMACHTIGDE

‘IK HEB EEN MASTER IN NATUURKUNDE EN FILOSO -
FIE. BIJ HET BEROEP OCTROOIGEMACHTIGDE KOMEN
MIJN LIEFDE VOOR HET BEGRIJPEN VAN NATUURKUNDE EN MIJN BREDE INTERESSE SAMEN. DE EERSTE
WEEK DAT IK BIJ ARNOLD & SIEDSMA WEKTE, KWAM
IK IN AANRAKING MET EEN NIEUWE METHODE VOOR
BETON STORTEN, EEN OPVOUWBARE SMARTPHONE
EN MET EEN VAGINALE RING DIE MEDICIJNEN AF -
GEEFT. HET IS LEUK OM TE WERKEN VOOR KLANTEN
AAN IETS WAT ZO BELANGRIJK VOOR ZE IS. VERDER
VIND IK HET AANTREKKELIJK DAT IK ER NOG EEN
JURIDISCHE OPLEIDING ERBIJ KRIJG.
STAN OTTE – TRAINEE OCTROOIGEMACHTIGDE
‘IK RONDDE AFGELOPEN JAAR EEN MASTER WERKTUIGBOUW-
KUNDE AF AAN DE TU DELFT. TIJDENS DEZE STUDIE VOND IK HET
LEUK OM BIJ ELK VAK WEER NIEUWE TECHNISCHE GEBIEDEN
TE LEREN, OM ZO ONTWERPEN WAARIN DIE TECHNIEK WAS TOEGEPAST TE KUNNEN ANALYSEREN. IN DIT BEROEP KOMT DAT OOK VEELVULDIG TERUG, ZOALS IN HET DOORGRONDEN VAN DE
UITVINDING VAN EEN KLANT. BIJ ELKE KLANT IS DIT WEER EEN
COMPLEET ANDER TECHNISCH PRODUCT. DAARNAAST VOORZIEN
WE KLANTEN VAN WAARDEVOL ADVIES OVER DE WAARDE VAN
HUN EIGEN OCTROOIEN EN DIE VAN HUN CONCURRENTEN. HET
VAK VAN OCTROOIGEMACHTIGDE IS EEN VRIJ BEROEP, WAAR JE
NIEUWE DINGEN BLIJFT LEREN EN JEZELF BLIJFT ONTWIKKELEN.’
31
A lease car? Extra days off? Double bonus? Sure, graduates ask those questions too. But more often the priority is finding meaningful work and only then considering the terms of employment. Claire Visée knows all about it. She is a career counsellor at the TU Delft Career Centre.
Visée aids students, PhD students, EngD trainees and young alumni as they take the next step in their careers and supports them in developing their career skills. Her workshops on negotiating in job interviews are invariably packed. According to Visée, the main aim is to give students more confidence going into negotiation. ‘Some are very reluctant to instantiate the conversation regarding (secondary) employment conditions,’ she says. ‘But it’s not at all a strange thing to start talking about, even if it’s for a job you really desire. It’s just a business deal.’ According to Visée, it is quite logical that such an interview is exciting, especially for international students who cannot always assess what is ‘normal’ within Dutch culture. ‘For many, it is the first time that they negotiate.
QUEST
To prepare them well, Visée and her colleagues engage in extensive discussions with students. ‘Make sure that you can indicate what you are good at and that you are clear about why a company appeals to you. These are important topics that come up in the preparation. More often, I get the answer that they want to work for a company that has impact. The company must add something to the world instead of ‘just making money’.’ These companies are not always easy to
‘Make sure that you can indicate what you are good at and that you are clear about why a company appeals to you’
TEXT PETER KOEHORST PHOTO OWN PICTURE INTERVIEW I 32
REGARDING EMPLOYEE BENEFITS
‘Negotiation is inherent’
find. Don’t let that stop you, according to Visée. ‘Persevere in your quest. Go to a business fair, for example. Find people who work at such a company and talk to them. Ask about the company, the culture and the work. Read up, be informed.’
‘YOU ARE ALLOWED TO NEGOTIATE’
The workshop on negotiation is also provided by Visée. ‘What I want to convey is that you are allowed to negotiate about employee benefits. Most employers are prepared for that. Is it difficult? That mainly depends on your stance on the matter. Sometimes, as a job applicant, you feel like you don’t want to be difficult or you really want the job and are afraid of asking too much. But also remember: you don’t always have to aim for the highest in negotiations. Sometimes you are just satisfied with the offer.’
‘WORKING FROM HOME OR HYBRID WORKING AS TREND’
Visée cites working from home and hybrid working as a trend. ‘Almost nobody is working full-time in the office since the corona period. Will it stay that way, or is the need to be in the office for five days a week increasing? That might be worth a lot in the future. ‘OK, I am willing to work five days at the office. Will there be appropriate travel reimbursement in return?’ See, that’s how you can negotiate.’
CLAIRE VISÉE HAS TWO TIPS TO MAKE THE MOST OF SALARY NEGOTIATION:

- ALWAYS TRY TO LET THE EMPLOYER COME UP WITH THE FIRST PROPOSAL. IT IS NICE TO HEAR FROM THE EMPLOYER WHAT SHE OR HE THINKS YOU ARE WORTH.
- DOES THE EMPLOYER PUT THE BALL IN YOUR COURT? GIVE A RANGE, NOT A NUMBER.
CLAIRE VISÉE OFFERS SOME TIPS TO GET THE BEST OUT OF NEGOTIATING EMPLOYEE BENEFITS:
- BE AWARE THAT YOU ARE ALLOWED TO NEGOTIATE. IT’S NOT WEIRD, IT’S ACTUALLY EXPECTED OF YOU.
- KNOW IN ADVANCE WHEN YOU WILL BE SATISFIED.
- DO A BENCHMARK WITH OTHER STUDENTS AND ALUMNI AND RESEARCH WHAT TO EXPECT.
- DON’T GET RUSHED. DO THEY MAKE YOU AN OFFER? TAKE TIME TO THINK ABOUT IT AND AGREE ON A DATE WHEN YOU WILL COME BACK TO IT.
- AND ABOVE ALL, PRACTISE A NEGOTIATION CONVERSATION. SUCH A CONVERSATION IS HARDLY A DAILY OCCURRENCE FOR ANYONE.
33 CAREER SPECIAL 01/2023
Your career. Start it your way.
Our possibilities for students and starters
Would you like to use blockchain technology to improve the food chain, figure out how to finance wind parks, or help to build the bank of the future? Starting a career at Rabobank opens the door to further growth, allows you to contribute to important, social issues.

Every year Rabobank provides more than 100 positions for trainees, young professionals, interns and starters. Explore our offer on rabobank.jobs/en/student-and-starter
Personal guidance
Rabobank invests a lot of time in developing young talent like you. From the very first meeting, we want to talk about what you know,
what you are capable of, and what you want to achieve—and we will keep asking about it. The working week includes time for personal development in addition to professional responsibilities. Besides training sessions to hone your hard and soft skills, you’ll also receive individual guidance.
Start it your way
Choosing a career at Rabobank opens the door to a lot of opportunities. You are part of a bank that at the centre of society, where your work contributes to a better bank ánd a better world. You get to know yourself, discover your talents and get every opportunity to start and shape your career in your own way.
Discover the details on rabobank.jobs
About working at Rabobank
A bank with a mission
Rabobank is a cooperative bank with a mission. Together with our stakeholders, we have been dedicated to creating a future-proof society and tackling major societal challenges for 125 years. In the Netherlands, we serve more than 9 million retail and corporate clients. Globally we focus on the food and agriculture sector, in more than 36 countries. Our starting point is: together we can achieve more than we could individually.
We embrace innovation, growth and sustainability, and invest in joint solutions that benefit everyone: our clients, their neighborhoods and the world. We also invest part of our profits in society – sometimes in your neighborhood, sometimes further afield, for example by helping Brazilian farmers.
We are involved in what is going on in society and in making the way in which we live and work more sustainable.
To do that, we focus on three major global transitions: food, climate and energy and the transition to a more inclusive society.
Are you starting your career at Rabobank?
Choosing a career at Rabobank opens the door to a lot of opportunities. You are part of a bank that is at the centre of society, where your work contributes to a better bank ánd a better world. You get to know yourself, discover your talents and get every opportunity to start and shape your career in your own way.
This is what we offer you
Growth opportunities
A Young Professional Program, traineeship, internship or starter position at Rabobank opens the door to a career full of opportunities in the financial sector, at a bank that is at the heart of society.

Young Rabobank
Join Young Rabobank, the network for young Rabobank employees, with more than 50 personal development activities, company visits and networking events.
Rabo@Anywhere
Work from home, head office, a local bank or from your holiday destination. At Rabobank you have the freedom to be flexible with your working hours and places.
Terms of employment
In addition to your salary, you will receive a work laptop and phone, a 100% compensation if you travel by public transport, a 13th month, holiday pay and an Employee Benefit Budget.
Personal development
Your growth is key. During the entire period that you work at Rabobank or do an internship, there is (in addition to your work tasks) all the space and time for personal development.
Expand your network
You become part of a large, international company where your network is rapidly expanding. You work in a multidisciplinary team where there is room for different personalities and where you learn from each other.
Fields of expertise
Data & Analytics, Digital & Innovation, Corporate Banking, Customer & Product, Financial Economic Crime, Finance & Risk, Human Resources, IT, Legal & Compliance, Marketing & Communication, Staff & Operations and Insurance.
Scan the QR code and read about the experiences of our Young Professionals.
aim was to graduate with distinction’
She travels around the world to film and help protect reptiles. Writer and presenter

WUR-alumna Sterrin
Smalbrugge (29) lives half of the year with her boyfriend in the Sierra Nevada in Spain. There are no terraria full of snakes or other reptiles. Quite surprising for someone who presented an educational show about reptiles, plays the main role in the Videoland programme Reptile-mad, has written two children’s books and one for adults about
reptiles, and is an ambassador for National Geographic Junior.
‘We’ve turned our house and its grounds into a paradise for nature. We’ve created a pond for toads and a rabbit warren, and hung up bat nesting boxes. In the evening we often switch off Netflix to enjoy our own gecko soap on the walls of our house. All sorts of intrigue goes on between those creatures.’
When Smalbrugge was a child, she and her father used to watch The Crocodile Hunter on Animal Planet, which was presented by Steve Irwin, an Australian animal expert with a penchant for reptiles. ‘I’m in love with all animals, and I get on better with them than with people. But I always thought it was strange and unfair that some animals have a higher cute factor than others. Why
do children have posters of lions or pandas on their walls and not of snakes? Steve Irwin was crazy about reptiles and I still remember an episode in which he, a tough crocodile hunter, wept buckets over the death of a crocodile. That made a big impression on me. He was my hero. When he died while filming, I decided at the age of 12 that, just like Steve, I wanted to speak up
A #2
‘My
Sterrin Smalbrugge has always thought it strange that some animals have a higher ‘cute factor’ than others. ‘I want to emphasize the sociable side of animals.’
STERRIN SMALBRUGGE
ALUMNA WUR
36 TEXT MARIANNE WILSCHUT PHOTOS OWN PICTURES ALUMNUS
WRITER AND PRESENTER
for animals that people are scared of.’
IN COMPARISON WITH STEVE IRWIN AND FREEK VONK, WHAT IS YOUR PRESENTATION STYLE?
‘The focus on TV is usually on the animals’ sharp teeth and other dangerous facts about them. To me it’s more important to highlight the sociable side of animals. The way the crocodile’s sharp jaw is used to carry its babies around, for instance. I’m not trying to say: look how brave I am with these dangerous animals. If you take away that over-the-top masculine bravado, girls can also think, hey, I could do that too.’
EVEN AS A STUDENT IN WAGENINGEN, YOU GAVE WELL-ATTENDED LECTURES ABOUT REPTILES.
I was very keen to do it. If I wanted to pass on my knowledge about animals, I had to get up and do it. It helped to do it with my Animal Sciences teacher Arie Terlouw. He gave me fantastic guidance. There wasn’t a herpetology department, but I took zoology courses with him and he sat with me for hours to expand my knowledge about reptiles. In that sense I was an atypical student. I hardly ever went out on the town. My aim was to graduate with distinction and apart from attending classes, I spent most of my time studying so I could learn as much as possible about reptiles.’
WHY DID YOU CHOOSE WAGENINGEN, EVEN THOUGH THE FOCUS THERE WASN’T ON REPTILES?
‘Leiden was a more obvious choice in that respect, but I looked into it in depth and attended a lot of open days. As a result, I knew when I was still at secondary school that I wanted to go to Wageningen. I think it’s important to study animals

as part of the ecosystem. Wageningen has a very good ecology department, and pays attention to the interaction between humans and animals. Besides, there is a lot of scope for personal supervision by teachers there. That is also why I am now doing my PhD with Frank van Langevelde in the Wildlife Ecology and Conservation Group. That personal contact is truly unique to Wageningen. When teachers see that you have a real passion for something, they give you plenty of scope for cultivating it. The more the university grows, the harder it gets for teachers to give students that kind of attention.’
STERRIN SMALBRUGGE
STERRIN IS CURRENTLY DOING PHD RESEARCH IN THE WAGENINGEN WILDLIFE ECOLOGY AND CONSERVATION GROUP, ON THE ECOLOGICAL TRAP HYPOTHESIS. SHE HAS WRITTEN TWO CHILDREN’S BOOKS: HET GROTE REPTIELENBOEK (THE BIG REPTILE BOOK) AND STERRINS REPTIELENREIS (STERRIN’S REPTILE JOURNEY), SHE PLAYED THE MAIN PART IN THE VIDEOLAND PROGRAMME REPTIELENGEK (REPTILE-MAD), AND IS AN AMBASSADOR FOR NATIONAL GEOGRAPHIC JUNIOR AND WAS CANDIDATE IN THE TV SHOW EXPEDITION ROBINSON.

EDUCATION
WUR MSC FOREST AND NATURE MANAGEMENT 2018
‘That’s right. I gave lectures about the king cobra and the hidden power of reptiles, and I held an evening on the anatomy of snakes. Those lectures were a real baptism by fire but even though I was nervous, of the populations of many species. That is part of what makes working with reptiles so nice – there is still so much scope for new, ground-breaking discoveries. I can really recommend it to students.’
A FEW YEARS AGO, YOU SAID TOO LITTLE RESEARCH WAS DONE ON REPTILES. HAVE THINGS IMPROVED SINCE THEN?
‘Luckily there have been some new discoveries since then, especially about the social life of reptiles. But there is still a lot of unexplored territory. We don’t even know the size
LIKE THE RESEARCH YOU WORKED ON INTO THE IMMACULATE CONCEPTION AMONG KING COBRAS, WHICH WAS PUBLISHED
‘I spent most of my time studying to learn as much as possible about reptiles’
37 CAREER SPECIAL 01/2023
IN NATURE SCIENTIFIC REPORTS THIS YEAR?
‘I got a phone call in 2015 from someone I know who keeps snakes and had a king cobra that had laid eggs without having had any contact with a male. I went to pick up the eggs with my then boyfriend, snake expert Romilly van den Bergh, and put them in the incubator. Two embryos from the 24 eggs proved viable. Both embryos, both males, survived for a few days. DNA research showed that what had taken place was parthenogenesis: immaculate conception. In parthenogenesis, during meiosis (the ripening of the egg cells), it is a polar body (a by-product of meiosis) that merges with
the egg, rather than a sperm. This happens in a different way every time, so that 24 unique gene packages were created, two of which turned out to be viable. We already knew that a few other species of snake, shark and lizard could reproduce without a mate, but this had never been proven in a king cobra before. We learned more about how the mechanism works during this study, which made it special.’
I GATHER KING COBRAS ARE GOOD MOTHERS?

‘They are the only species of snake that makes a nest for the eggs and guards it. Now their habitat in South-east Asia is under pressure, partly
because of the expansion of palm oil plantations, cobras are moving into farmland, where they run the risk of being killed by farmers. I made a documentary for The Conservation Front about Bali Reptile Rescue, which tries to save these snakes. The Conservation Front is a nature conservation organization I set up with wildlife photographer Jason Savage. As we were filming, Shinta, the woman behind Bali Reptile Rescue, passed me the hook so I could catch the snake. That was my first rescue operation, and it had me in tears afterwards.’
I myself have made a few minidocumentaries and I travel around the Netherlands and Europe for my programme Reptile-mad, making items about unusual reptiles such as wild chameleons. There are interesting reptiles close
to home as well, and you don’t have to travel to exotic places to find them.’
IS YOUR PHD RESEARCH ABOUT REPRODUCTION IN REPTILES?
‘No, that is about the ecological trap hypothesis. Animals use evidence from their surroundings to find new habitats, but they can make wrong choices if a habitat seems more attractive than it really is. Dead reptiles and amphibians are often found in irrigation channels and water troughs for livestock. I want to find out what triggers attract them to such places, and why they die there. In my spare time and on holiday, I’m always nosing around wells and water tanks, saving reptiles and amphibians. I am busy with reptile conservation all the time.’
‘In my spare time and on holiday, I’m always nosing around wells and water tanks, saving reptiles and amphibians’
38
Een betere omgeving voor mens en natuur waar bedrijven op een verantwoorde manier kunnen blijven ondernemen? Daar staan we als omgevingsdiensten voor!
Is werken bij een omgevingsdienst iets voor jou?
Start hier!
Wil jij werken aan een fijnere omgeving om in te wonen?
Ga jij net zo lang door tot je een oplossing hebt?
Bijt je je graag vast in één onderwerp?
Het werken bij een omgevingsdienst past niet bij jou.
Hopelijk vind je snel iets dat wel bij je past!
Noemen ze jou ook weleens een echte puzzelaar?
Houd je van het voeren van een stevige discussie?
Honderden pagina’s aan onderzoeksresultaten doorspitten om tot je antwoord te komen?
Werken bij een omgevingsdienst past bij jou. Zeker in de functie van vergunningverlener.
”Van een bedrijf dat wil uitbreiden naast een woonwijk tot de wens voor een hardstyle festival middenin een natuurgebied. Wij behandelen verschillende soorten aanvragen en maken afspraken over wat wel en niet kan.”
Vergunningverlener Angela
Ga je er graag op uit?
Werken bij een omgevingsdienst past bij jou. Zeker in de functie van toezichthouder/ inspecteur.


“Geen dag is hetzelfde. We informeren bedrijven over de milieuregels, letten op bouw- en brandveiligheid en controleren in kwetsbare natuurgebieden. Wanneer nodig handhaven we.”

Toezichthouder Iris
Werken bij een omgevingsdienst past bij jou. Zeker in de functie van specialist.
“Bodem, lucht, geluid, energiebesparing, ecologie, externe veiligheid, afval, zwemwater, circulaire economie… We hebben veel expertises in huis. Dat zetten we in om de meest lastige vraagstukken in de regio op te lossen.“


Specialist Mark
Meer weten? Scan de QR-code!
JA NEE NEE JA JA
NEE JA
NEE JA
JA JA
NEE
NEE NEE






















































More than most people he is aware that knowledge is power. ‘As a cyber security expert, you can’t afford not to be informed about the most recent developments. I need to know what new tactics attackers will use, so I can help clients defend their organisation. Or even better: be a step ahead of the hackers and pro-actively create smart solutions. The cyber community on Twitter plays an important role in this. We help each other, no matter where or who you work for.’
Just as extensive as his knowledge, is Olaf’s passion for his job, which is increasing every day. Or rather: with every hack and every challenge. ‘For me and most cyber security experts, it all started at high school. Experimenting with computers, building your own hardware or website, and continuously improving yourself bit by bit. I was good at programming, so Information Technology at University of Twente seemed the right option for the

future. Did I know what I wanted to do with it? Not at all. But you learn along the way. Just before I graduated, cyber security drew my attention. Because of an invitation for Capture The Flag (CTF), fondness became focus. I wanted to do more in this field.’
‘Challenges are key for my job, and the other way around. The more I play, the bigger my mental library. What can I use in which case? What are the shortcuts and what risks are involved? Everything I try and learn during a challenge, I bring to client cases. And everything I learn on the job during a project for a client, I use to conquer that flag.’
BLUE TEAM, RED TEAM, ONE TEAM
Within Deloitte, Olaf works in the socalled “blue team”, or “team vigilant”. This is the defending team, which exists next to the “red team” which is responsible for attacking. This is army jargon. During Red Team testing military units test each other for weaknesses and vulnerabilities. The Red Team attacks the Blue Team. ‘We work in five teams: strategy (how can companies become more resilient?), offense (ethical hackers who expose vulnerabilities), digital ethics and privacy (what is the impact of digital technology such as machine learning), identity and access management (how can we make the login process as safe as possible), and team vigilant – my team. We focus on monitoring, security engineering and instant response: acting on an incident. Sometimes it’s a small-scale incident, with a virus alert on one laptop, so we need to limit the risk of more damage. And sometimes it’s a largescale incident – with ransomware.’
ADVERTORIAL 42
‘We help each other, no matter where or who you work for’
OLAF HAALSTRA, INCIDENT RESPONSE TEAM
‘It’s a game of cat and mouse. They are on one side of the computer, we’re on the other side. The question is: who is going to win?’ Olaf Haalstra (27) is a Consultant in the Deloitte Incident Response Team, fighting cyber criminals who are attacking large organisations.
BACK TO THE SOURCE
‘Just imagine there’s a ransomware attack. In that case, we need all login information as soon as possible. Preferably, the client uses SIEM (Security Information and Event Management). That means all crucial logs are in one central location and hopefully we are able to find the source of infection there. If there is no central recording location, we use forensic copies of as many servers and laptops as we can find. In case we’re in a bigger hurry, we use triage scripts – only the logs and artifacts of servers and laptops that are required for the investigation. Our goal is to retrieve where attackers have been – and where not –and to which systems they had access or no access.’
CONTAINMENT, ERADICATION, RECOVERY
‘Solving the security breach consists of three stages. Stage one is containment:
preventing the hack from spreading further. Stage two is eradication: cutting the hacker’s access off so they can’t be in control again. Sometimes that’s just a matter of literally unplugging from the internet. Eventually, what is the most practical and sustainable solution depends on the situation. Stage three is recovery: operation “cleaning” and starting up again. In case of malware, the first step is to delete the malware and change all passwords. If necessary, we can install a better firewall. The sooner the better. As soon as an infection has been detected in one part of the company, it’s a matter of hours before the attackers can also infect other parts. So it’s key to isolate these parts. If everything is locked and it’s a large company, it could take weeks before you’re up and running again. So in case of a large infection, we always assess which parts can start up again before there’s a reinfection.’
THE GOLDEN TRIANGLE OF EFFECTIVE SECURITY
Almost all cybercrime experts share this passion, but it’s not always the technological component, Olaf explains. ’Cyber security consists of three components: Human, Technology and Process. Your technology is as good as the people who work with it. Maybe you have developed a wonderful security tool, but your employees think it’s too much trouble. In that case, they won’t use it, and all your good work is in vain, with all kinds of consequences. You need the right processes to convince people of the how and why. That’s why it takes so many different people, passions and disciplines. In our department alone, there are more than 350 professionals, each with their own discipline to which they are fully dedicated. Only by using that diversity we will be able to win the game of cat and mouse.’

43 CAREER SPECIAL 01/2023
Een baan met impact
Wil je werk doen met impact? Werk dat écht het verschil maakt. Bij de provincie Noord-Holland bouw je mee aan je eigen toekomst en die van 2,9 miljoen inwoners. Inspirerend. Innovatief. Duurzaam. Urgent.


Bij de provincie geef jij de bereikbaarheid van de toekomst vorm. Wist je dat Noord-Holland 600 kilometer wegen, 250 kilometer vaarwegen, 50 kilometer ov-banen, 400 kilometer fietspaden, 10 sluizen en ruim 550 bruggen heeft?

Jij helpt met het vernieuwen, onderhouden en beheren van de infrastructuur in de hele provincie. Bouw jij mee aan het Noord-Holland van morgen?

noord-holland.nl/werkenbij
Life hasn’t always been kind to Kisanet Molla, but not even war and personal tragedy have broken her spirit. ‘I see problems as opportunities. I don’t want to be restrained by them, I want to contribute to solutions,’ says the young alumna of the University of Twente. Right after acquiring a degree in Spatial Engineering in 2021, she co-founded SEWOB, a start-up using geo-spatial technologies to address wicked problems of the world.
Kisanet Molla was born and raised in Tigray, a northern region of Ethiopia currently at war. She comes from a large family of eight siblings, who lost their mother at a young age. ‘I would be nothing without my family,’ she says repeatedly. Unfortunately, Kisanet hasn’t been able to talk to or see her loved ones in Ethiopia for months. ‘All communications have been cut off due to the war,’ she explains. On top of that, the alumna would not be able to safely return to Tigray. She has been actively advocating for the war in her home country to stop, placing herself in a dangerous position.
DREAMS AND DRIVE
The alumna hasn’t given up on her dreams, though. ‘The drive to run my own company has always been there,’ she says. After she had to put her first company Deamat on hold, she is now busy with two new adventures. ‘I started a foundation Tigraihub.org focused
on education and entrepreneurship. It offers young people an opportunity to explore and connect with experienced people in their diverse fields. Among other things, it contains online education for people in Tigray and those directly impacted by the war.’

TASKFORCE
Together with three other University of Twente graduates, Kisanet is also running SEWOB, Spatial Engineers without Borders. ‘I like to think of us as a taskforce that provides solutions to wicked problems,’ explains the alumna. ‘The idea to start this company came during COVID-19. We were all sent home to sit and wait. And I thought: but this is not what we were trained to do! Spatial Engineers come up with solutions, not just wait for them. I wanted to start a company that uses everything we have been learning in the study programme and came up with the idea of SEWOB.
We are empathic social engineers focused on solving complex problems using state-of-the-art geo-spatial technology.’
PLANNING SYSTEMS
At the moment, SEWOB mainly aims to support countries with weak planning systems. ‘We are only just beginning, but most of our projects will be related to social problems in developing countries. I’d like SEWOB to be one of the top players and contribute to solving problems of our world, such as food security,’ says Kisanet. ‘I really love being able to work within spatial engineering. The field gives you a lot of freedom to come up with your own creative ideas. The sky is the limit.’
45 STARTUP TEXT MICHAELA NESVAROVA PHOTO RIKKERT HARINK CAREER SPECIAL 01/2023
S #2 SEWOB
‘Spatial engineering gives a lot of freedom’
“I like turning science fiction into reality”
Karim El Assal is a system integrator and technical lead in TNO’s Networks department. As a software developer, he feels at home in the network department as he’s working on the communication applications for social extended reality networks. By doing so, Karim is making his mark on the communication networks of the future.
“At TNO, i’m working on a large project called ERP Social XR, in which I lead the software development at the integration level. This is all about virtual reality, augmented reality and the new means of communications that these altered realities enable. Examples include meetings in which you can look at a 3D object together or really want to feel like you’re in the same room. But there’s also healthcare applications, through which can you be ‘in the room’ with the elderly, so to speak. Or ‘remote expertise’, where you allow an expert to be present virtually.”
MAKING A MARK ON OUR TIME
“I first did a bachelor’s in Advanced Technology at the University of Twente,

followed by a master’s in Computer Science with a focus on Software Technology and Data Science. I began working at TNO immediately afterwards. I remember going to the job interview wondering what I could do at a networks department as a software engineer. That was, until the research manager told me about the Social XR projects. I was enthusiastic right away as I like turning science fiction into reality. Extended reality is one of the steps that will ensure that we can live in a future which we now see in films.”
THE FREEDOM TO ORCHESTRATE YOUR OWN WORK
“On top of that, innovation is central at TNO, as is the desire to contribute something to society. That’s the kind of organisation I want to work for. The size of the organisation also played a part: it offers so many opportunities to actually shape innovation. And TNO’s flexibility appealed to me immediately: you can choose when you work and what you work on. When you’re just starting out, they don’t say: here’s a job, go and work on it for 4 or 5 days a week. You have to find your place yourself. To me, that’s completely positive as it gets you to where you want to be – you have the freedom to specialize on a certain topic
or to hop to a different job type and work on something new.”
THINKING ABOUT THE LONG TERM
“My work used to revolve around software development. It has now become more focused on system architectures and integration – and on leading projects and their technical designs. I’m also leading the development of the open source strategy and a TNO-wide initiative to improve our overall code quality. What I want in the future? To become a CTO at a start- or scale-up. My work at TNO fits that ambitionEspecially given the fact that TNO has a lot of spinoffs, where knowledge developed by TNO form the basis for start-ups.”
AT TNO YOU CAN MAKE YOUR MARK ON OUR TIME BY WORKING ON INNOVATIONS THAT MOVE SOCIETY AND BUSINESS FORWARD. INTERESTED IN CONTRIBUTING TO A SAFE, HEALTHY, SUSTAINABLE AND DIGITAL WORLD? CHECK OUR VACANCIES ON TNO.NL/CAREER
ADVERTORIAL 46
Less screen time on your phone thanks to startup Unpluq
‘We understood product design and production, but not marketing. On three separate occasions we had to look for someone who understood marketing and sales that was also willing to cooperate.’
BELIEVING IN YOUR PRODUCT
Smits understands why it is so difficult to find committed employees. ‘It’s a big risk to get into a startup, because you don’t have a lot of security. Moreover, you have to do something you don’t know a lot about, without knowing whether you are making the right choice. You must fully believe in your own product.’
Meanwhile, in addition to the small USB stick, Unpluq has launched an NFC tag. This too should help reduce smartphone usage, but is less easily broken by bending the USB plug. In addition, there is now an app that does not even require a USB stick or NFC tag to block apps. More than fifty thousand people have now tried an Unpluq.

Currently, Unpluq is still dependent on investors. ‘Setting up a software company is something that takes a lot of money, time and energy, and the market is very uncertain,’ Smits said. When the app version was released, Smits and Rigter received emails from users. ‘They were disappointed that the physical component, the stick or tag, was no longer there. In the end, just shaking your phone to use apps does lead to a lower threshold to grab your smartphone.’
The data also showed the difference in smartphone usage between people with the USB stick or tag and those with the app. People who physically blocked their smartphones saved about eighty minutes of screen time per day, app users only thirty to fifty minutes.
During his master’s degree in Design for Interaction (TU Delft), his participation in the course ‘Build your Startup’, which revolved around starting his own startup, lead Smits to do something about this smartphone usage. With fellow student Jorn Rigter he started Unpluq, a company that makes it possible to temporarily block certain apps on your smartphone through a small USB stick-like device attached to the USB port. ‘If the device is in your phone, you have access to all your apps. If you take it out, they are blocked,’ Smits says. ‘Exactly because it’s an annoying little thing, you want to have it in your phone as little as possible.’
After designing the first prototype, Smits and Rigter set up crowd funding in the early 2020s. They sold about 350 copies of the small USB sticks in the first phase and raised ten thousand euros through Leapfunder, a platform where many investors help small business es get started. With that, the product could be developed further. That was a particularly difficult phase, Smits and Rigter noticed.
For Smits, the emails Unpluq received from its users are a good lesson. ‘You should always keep in close contact with the people who are using your product.’

It is well known by now that a phone addiction can lead to problems related to focus and a sense of purpose in life.
During his college years, Tim Smits also regularly suffered from prolonged smartphone usage. ‘I slept less well and got distracted while studying.’
START-UP TEXT ROB VAN DER WAL S 47 #3 CAREER SPECIAL 01/2023
UNPLUQ
Aan de slag voor de provincie Zuid-Holland!
Wij zijn de provincie Zuid-Holland. Met 1.700 medewerkers werken we aan – vinden we zelf – het meest interessante stukje Nederland. Bedrijvig, veelzijdig, innovatief en met 3,6 miljoen inwoners de dichtstbevolkte provincie. We hebben zee & duinen, gevarieerde polderlandschappen, historische dorpskernen, grote steden, moderne architectuur en toonaangevende musea. En er zit veel kennis; er zijn in Zuid-Holland 3 topuniversiteiten gevestigd die hun kennis overdragen aan zo’n 74.000 studenten.
WAT DOET DE PROVINCIE
ZUID-HOLLAND EIGENLIJK?
We horen vaak dat mensen geen idee hebben wat een provincie doet of wat mensen doen die bij de provincie werken. We hebben een divers werkveld; van het organiseren van openbaar vervoer tot aan het inrichten van natuurgebieden en het versnellen van woningbouw. Aan deze opgaves werken we samen. Van techneuten, financieel specialisten en de catering. Van werktuigbouwkundigen tot data-analisten. Van storytellers tot beleidsadviseurs op de meest uiteenlopende terreinen. Maar ook IT-ers, communicatieadviseurs en juristen. Je maakt echt impact op je omgeving. Het werk dat je doet is zichtbaar en dat maakt het leuk. Je kunt aanwijzen waar je aan werkt, in het echt of op de kaart. Of je wandelt of rijdt letterlijk door je eigen project. We werken met trots aan maatschappelijke vraagstukken van morgen. We zien volop kansen, juist in Zuid-Holland, omdat hier veel samenkomt. Samen met inwoners, medeoverheden, bedrijven, kennisinstellingen en maatschappelijke partners werken we aan oplossingen. Deze diversiteit biedt kansen én zorgt voor uitdagingen, zoals de provincie bereikbaar houden voor iedereen en tegelijkertijd slim omgaan met de schaarse ruimte en het versterken van de natuur. Door daar samen aan
te werken, maken we Zuid-Holland elke dag beter! Met jouw energie en vakmanschap kun je echt iets betekenen voor de regio, de inwoners en de bedrijven in Zuid-Holland.
WERKEN VOOR DE PROVINCIE ZUID-HOLLAND
Werken bij én voor onze provincie betekent dat jij hier een rol in speelt. Dat doe je nooit alleen, want alles raakt elkaar. Daarom zoek je altijd afstemming en overleg met partnerorganisaties en je collega’s op verschillende vakgebieden. Binnen onze organisatie werken we aan innovatie. Op het gebied van data en technologie zijn we al best ver, maar we willen ons hier nog verder in ontwikkelen. We richten ons niet op de minimale eisen, maar pakken door om de rol van digitale overheid echt goed in te vullen.
SAMEN DE PROVINCIE ELKE DAG BETER MAKEN?
We zijn niet alleen een interessant stukje Nederland, maar ook een interessante overheidsorganisatie. Als middenbestuur zitten we letterlijk tussen de Rijksoverheid en de gemeenten in. Praktischer dan het Rijk en een grotere scope dan een gemeente. Groot genoeg om echte impact in de regio te maken en klein genoeg voor korte lijnen. We zijn een platte organisatie,
waar veel ruimte is voor eigen inbreng van medewerkers.
Als werkgever hebben we vertrouwen in onze mensen en hun expertise. We zorgen goed voor je en je krijgt veel ruimte voor eigen inbreng en initiatief. Maar je moet het wel zelf willen en zelf keuzes durven maken. De kaders zijn niet altijd duidelijk. Je moet bij ons een beetje van zwemmen houden. We stimuleren hybride werken en faciliteren daarnaast het inrichten van een eigen thuiswerkplek waarbij de gezondheid van onze collega’s voorop staat.
PROVINCIE ZUID-HOLLAND

GA JIJ SAMEN MET ONS AAN DE SLAG OM ZUID-HOLLAND #ELKEDAGBETER TE MAKEN? WE HEBBEN OOK EEN PRACHTIG TRAINEE PROGRAMMA EN RUIMTE VOOR STAGIAIRES. DUS BEKIJK DE WEBSITE VOOR
MEER INFORMATIE, VACATURES, ARTIKELEN EN VERHALEN VAN ONZE COLLEGA’S!
WWW.WERKENVOOR.ZUID-HOLLAND.NL

ADVERTORIAL 48
Henk Arntz has big ambitions in sustainability

Last year, Henk Arntz, CEO of Suncom Energy, marched away with the Industry Innovators Award, having won both the jury prize and the audience prize. With this startup Arntz, TU/e alumnus of Mechanical Engineering, wants to build the Netherlands’ first concentrated solar thermal energy storage facility, using compact parabolic mirrors to supply renewable heat.
Suncom Energy is flourishing. Its workforce, continuing to expand and installed in new office premises in Houten, is tackling the question of how concentrated solar energy can make industry more sustainable. The key players are the parabolic mirrors that heat a liquid by capturing and concentrating sunlight, explains Arntz, his enthusiasm vibrant. Forget the standard giant format of 7x100 meter, Suncom
has made its mirrors more compact; so that the individual modules now fit into a shipping container. Whereas today’s solar thermal power plants based on high-temperature concentrated solar power (CSP) are large-scale installations, Suncom aims to produce smaller and therefore cheaper installations. ‘We want to move away from long rows of mirrors in the desert to filling just half a soccer pitch.’
MAGNIFYING GLASS
The compact mirrors are uniquely able to heat liquids to temperatures around 500 degrees Celsius. They’ve got his scouting past to thank for this, Arntz admits. ‘I’m sure you’ve tried using a magnifying glass to start a campfire. The thing to remember is the smaller the focal point, the greater the heat. By using a square rather than a circular
surface, we saw that the concentration of sunlight could be increased by up to 50 percent. So now in the collector we use square ducts instead of tubular ones. As a result, the liquid being pumped through them can reach a temperature of 500 degrees Celsius, which makes this system appealing to industry. Not only can we use this technology in district heating systems and to heat glasshouses and food processing plants, it can also be converted into electricity. And this means the system can supply renewable heat and electricity 24 hours a day.’
COMPACT SNOW
This is not his first run at setting up a business. Arntz started his first company, Snocom, back when he was studying. His plans for a snow remover came to fruition: the Snowcuber can compress
a hundred cubic meters of fresh snow into a dump truck load of 18 cubic meters. Purchasers include Schiphol, Paris and Helsinki. In 2018 he sold Snocom to a supplier. ‘I’ve had my entrepreneurial spirit from an early age. After Snocom I spent a short while working in consultancy to broaden my horizons, but I much prefer being my own boss.’
The TU/e connection figures prominently in his team at Suncom Energy; his partner Wout Gubbels, who was also involved in Snocom, is a former fellow student. ‘I have a lot of contact with people I was at TU/e with, people from all walks of life. People fan out in all directions, find new jobs or start companies – but there’s always something you have in common.’
ARNTZ ALUMNUS TU/e
HENK
OF SUNCOM ENERGY A ALUMNUS TEXT NICOLE TESTERINK PHOTO LORAINE BODEWES #2 49 CAREER SPECIAL 01/2023
CEO
Met werken bij de AIVD draag je bij aan de veiligheid van Nederland
DWIGHT WIL WAARDE TOEVOEGEN AAN DE SAMENLEVING
Toen Dwight hoorde dat de Algemene Inlichtingen- en Veiligheidsdienst (AIVD) een lezing over het verwerken van data zou geven bij zijn opleiding, zorgde hij dat hij die dag in de zaal zat. Die presentatie sloot voor een groot deel aan bij zijn studie Computer Science and Engineering
Hij was op zoek naar een interessante plek om zijn scriptie te schrijven. De vonk sloeg over.
Voor hem was het duidelijk dat hij niet in het bedrijfsleven wil werken: Dwight wil waarde toevoegen aan de samenleving. Na afloop sprak hij met de man die de lezing gaf. Die was verrassend open en benaderbaar. Toen wist Dwight
zeker dat hij een poging wilde wagen om af te studeren bij de AIVD. Dwight kwam terecht op de plek waar hij wilde zitten. Hiervoor moest hij wel eerst een veiligheidsonderzoek ondergaan van een paar maanden, zoals iedereen die bij de AIVD gaat werken.
WERKEN MET DE NIEUWSTE TECHNIEKEN
Het onderzoek van Dwight richtte zich op het ontwikkelen van een nieuwe applicatie voor het inlichtingenproces. Inlichtingenwerk raakt het hart van de organisatie; applicaties mogen echt niet uitvallen. ‘Die verantwoordelijkheid voelde ik heel sterk’, vertelt Dwight. ‘Elke organisatie zegt dat ze met het nieuwste van het nieuwste werken, maar bij de AIVD is het echt zo. De
door mij ontwikkelde applicatie maakt gebruik van de standaardtalen. Bij andere overheidsorganisaties is er nog wel eens aarzeling over de adoptie van nieuwe technieken, bij de AIVD is dat absoluut niet het geval. Hier mogen we ook dingen van buiten naar binnen halen, als we zeker weten dat het veilig is.’ Dwight voelde zich zo thuis bij de AIVD dat hij na zijn afstuderen in dienst ging als full stack developer. Hij heeft het nog steeds goed naar zijn zin. En kan nu met zijn salaris nadenken over een echt goede gitaar, want dat is zijn grote hobby. Dat hij met zijn werk dagelijks bijdraagt aan het vinden van oplossingen voor praktische en wezenlijke problemen vindt hij heel fijn. Zijn collega’s komen veel sneller


ADVERTORIAL
OP WERKENBIJDEAIVD.NL 50
BEN JE NIEUWSGIERIG EN WIL JE MEER WETEN? LEES VERDER
tot de kern door de oplossingen die hij bedenkt. Voorlopig zit Dwight goed op zijn plek. Misschien gaat hij die PhD nog wel eens doen bij de AIVD of MIVD en misschien wil hij ook nog wel eens leiding gaan geven aan een team, ooit. Die doorgroeimogelijkheden zijn er.
KARIN WIL HET ALGEMEEN BELANG DIENEN
Wat Karin het allerleukst vindt aan haar werk? Samen met haar collega’s een systeem of verbinding zo goed beveiligen dat zelfs een hacker in dienst van een buitenlandse overheid of quantumcomputer er niet bij kan. Dit zijn uitdagingen waar zij zich dagelijks als cryptoloog van de AIVD over mag buigen.
De AIVD voldoet aan alle eisen die Karin stelt aan een werkgever.
Met haar opleidingsachtergrond in Wiskunde en een aantal jaren onderzoekservaring, was Karin op zoek naar een interessante werkomgeving, waar
ze met haar opgedane kennis echt het verschil kon maken. Die waarde vond ze in het dienen van het algemeen belang en het bijdragen aan de veiligheid van Nederland. Staatsgeheimen bij de Rijksoverheid, vitale processen in het bedrijfsleven of communicatieproducten van militairen die op missie gaan: het zijn een paar voorbeelden van situaties waar je kwaadwillenden en statelijke actoren buiten de (digitale) deur wilt houden.
VRAAG NAAR BEVEILIGINGSPRODUCTEN
De AIVD krijgt regelmatig verzoeken van overheidsorganisaties en bedrijven uit de vitale sector voor het ontwikkelen of evalueren van beveiligingsproducten. Karin werkt hiervoor samen met een multidisciplinair team van cryptologen, hardware-, softwareen netwerkexperts. Nadat eerst alle mogelijke dreigingen in kaart zijn gebracht, bepaalt Karin de criteria waaraan het product moet voldoen.

Die voorwaarden zijn niet alleen gebaseerd op eigen onderzoek en ervaring, maar ook op externe cryptopublicaties. De keuze voor deze werkgever was wel iets dat ze eerst goed met haar partner heeft besproken. Werken bij de AIVD heeft namelijk wel impact op je persoonlijke leven. Inhoudelijk kun je weinig delen met je naasten en thuiswerken is meestal geen optie. Maar dat laatste heeft ook weer zijn voordelen. Zéker voor iemand die het lastig vindt om niet naar haar werkmail te kijken als ze thuis is. Nu kan Karin lekker gaan sporten of onderuit zakken voor een fijne serie. Die goede werk-privébalans bij de AIVD gaat ze steeds meer waarderen.

51 CAREER SPECIAL 01/2023
Inventing machines from day zero, that is what System Architect Kees loves to do. He has been working at NTS for over seven years and talks about his work, colleagues, and the importance of cooperation at NTS.

nts-group.com
“If you ask me, I have the best job in the Netherlands,” Kees says. “This is because I provide technical leadership to a team of people who devise a machine for a customer. Our customers often come in with very abstract and general ideas. When we ask them about the underlying problem, we’re given very interesting explanations and it often turns out there is a sublayer to the question. The human aspect of our job is great, you are involved in project meetings with a customers from day one”.
Kees feels the human aspect is also very visible in the way in which everyone cooperates at NTS: “We come up with new machines together with a group of specialists. I am personally not a star in optics, for example, but fortunately I get to ask help from an opticial engineer here when necessary. We discuss every milestone of the project together and get to make a technically successful solution as a team.”
Your added value is high
Because Kees is involved in projects from A to Z, he finds that his work is incredibly diverse: “A day or month is never the same because you are not constantly working on just one small part of a machine. You get to start with the concept, ask the customerfor feedback, build the concept, then fine-tune it, and so on. As a result, your added value as an individual is very high. You really help customers.”
Sharing knowledge is one of the constituents of NTS
Apart from his job at NTS, Kees expands his knowledge even further. He teaches as a lecturer at the High Tech Institute in Eindhoven, for instance. “I enjoy sharing knowledge.Even though teaching is something I do outside NTS,
Accelerating the future
it is definitely encouraged. It gives me real satisfaction when I see a spark ignite in others. The thought ‘look, that person has really learned something today’, brings a successful day for me too.”
“Within NTS I am working on structuring competences. These are technical fields within our company, such as dynamics and mechanics. We are constantly working on building knowledge and then putting it at the service of our customers. Sharing knowledge is really a part of the building blocks of NTS.”

Kees: “There are often many different people in a team. But that’s what you need, different characters in different roles. After all, I think a certain depth in a project is important. I am not a project manager: I want to know what the situation is and what is needed to move forward. That technical probing, but at the same time not losing sight of our people, that is the most important thing in my job.”
The key to success
“We never really lose sight of each other,” says Kees. “NTS is a family business, people care about each other, and the team spirit is enormous. If you need help, colleagues will put their own work aside. Sometimes you need to support someone who needs crucial help before you move on with your own tasks. You wouldn’t want to have an entire team waiting for an answer after all. That would delay their project and that is something we obviously want to avoid. Helping each other is the key to success.”
“Helping each other is the key to success.”
GROW FURTHER WITH TCPM
We think our profession is the best there is. The continuous challenges and working together on the best solutions give us enormous energy. Innovations within the industry follow at a rapid pace, so there is no time to stand still for us either. With around 250 employees, we have a wealth of knowledge and experience. We gladly share this with each other and expand it daily. This is how we remain leading in our area of expertise.
From our own TCPM Academy, we stimulate everyone’s ambition and challenge you to keep growing. Even after your studies. We ensure that you fully use your unique talents. It is equally important to us that you are doing well, that you feel good about yourself and get satisfaction from your work. We support you in your personal development and facilitate you with various learning programmes, so you can profile yourself via your own route.
KICK-START YOUR CAREER
Are you curious about how TCPM can kick-start your career? And do you want to learn about the progressive projects you can work on? Our mechanical engineer Bart Schreurs would like to take you through his career and work at TCPM. Watch his video and the stories of several other TCPM employees via the QR code or at our website www.werkenbijtcpm.nl.

“TCPM MAKES ME FEEL CONFIDENT AND OFFERS THE OPPORTUNITY TO GAIN A LOT OF EXPERIENCE WITH VARIOUS CLIENTS AND PROJECTS IN DIFFERENT INDUSTRIES.”
- mechanical engineer Bart Schreurs
With our expertise in the field of engineering, project management and industrial safety, we offer a coherent package of services. This enables us to provide complete and integrated solutions for industrial customers. We do this from our five offices spread throughout the Netherlands, optionally (partly) from home or at the customer’s premises.
 TCPM ACADEMY
ABOUT TCPM
TCPM ACADEMY
ABOUT TCPM
Better from farmer to baker
The Zwamcijsje tastes, looks and sounds exactly like a well-made saucijzenbroodje, the Dutch sausage snack. A crunchy exterior and a moist, tangy-flavoured filling with a bite. However, this snack is a lot better for the planet. It is ‘the next step after vegan’, inventor Mendelt Tillema argues.
Saucijzenbroodjes are the bakery products with the highest environmental impact. They are filled with animal-based fat: meat, butter and eggs. But they are delicious. Meldelt Tilleman, the driving force behind the Wageningen start-up that developed the Zwamcijsje, agrees. The Zwamcijsje, however, is entirely plant-based, with a mushroom filling. The idea for the Zwamcijsje emerged when Tillema was asked to design a future-proof product during a course in Meat Technology and Alternative Proteins after graduating in Plant Sciences at WUR. ‘It aligned with a request from a large catering business to design a leaner saucijzenbroodje’, says the food innovator.
Opting for mushrooms was an obvious choice, says Tillema. ‘The natural flavour and texture of the oyster mushroom fit the product like a glove’, he states. The flavour comes from the stems of the mushrooms, which are sustainably and locally grown. One of the advantages of mushrooms is that they don’t need fertile soil to grow: oyster mushrooms are cultivated on a substrate, this consists of straw. A sustainable choice, Tillema clarifies. ‘Grains are the world’s largest crop. However, over half of the crop consists of straw, which has a limited function within the food chain due to its high lignin content. Lignin is a substance contained in the cell membrane and cannot be digested. However, oyster mushrooms love it.’ In the highly unlikely event of a shortage of straw, a different substrate can easily be used. ‘Mushrooms are extremely efficient in converting different types of residue streams’, he explains.
The Zwamcijsje is open about its origins. Tillema promotes it as the ‘next step after vegan’. This shows that, in its marketing, the focus lies not on the missing ingredients (meat) but on the advantages of the product: plant-based, considerably fewer emissions and between thirty to fifty per cent less fat than the regular saucijzenbroodje. Chefs, bakers and even food engineers are positive about the texture and flavour of the Zwamcijs. Those wanting to taste the snack must resort to food professionals and chefs because the product is available only at a selected number of business-to-business suppliers. There are, at present, no plans to sell to private parties. ‘We know the professional distribution channels well, and we work with buyers that understand how unique this product is. This approach gives us enough room to grow, for now, says Tillema. So, there is no alternative but to request your favourite restaurant add the Zwamcijsje to the menu.

ZWAMCIJSJE START-UP TEXT MARIEKE ENTER PHOTO LIZE KRAAN S 55 #4 CAREER SPECIAL 01/2023
WILL YOU MAKE THE DIFFERENCE IN THE WORLD OF TOMORROW?
Do you like technical challenges in mechanical engineering, mechatronics, electronics, software and IT? Then VDL is the perfect match for you!


In the worlds of Science, Technology & Health, Mobility, Energy & Sustainability, Infratech and Foodtech, VDL develops and produces a wide variety of industrial and innovative products and machines, from parts to end products. We are always driven to make the difference together. By thinking, by doing and by combining craftsmanship and innovation.
START YOUR CAREER AS:
• Management trainee
• Factory engineer
• Mechatronics / Mechanical engineer
• Software engineer
• Sales engineer
• Purchaser
Check out werkenbijvdl.nl
STRENGTH THROUGH COOPERATION
I’M PROUD TO WORK ON COMPLEX PRODUCTS AT THE FOREFRONT OF TECHNOLOGY.
Life at Nedap
Being in the lead of your career and your own personal development, it can go as far as working remotely while travelling the world. After doing her graduation internship at Nedap for her master’s degree, Kelly (27) was offered the chance to kick-start her career at the company. And she took it…starting off with a one-year trip to Australia, that is.


"After my studies, I first wanted to travel. At the same time, I had discovered I also really wanted to develop further in the technical field after graduation. I could stay at Nedap after completing my graduation project, so was I going to go for security and a job or still travel first? I decided that I should just put my wishes on the table, so I told Nedap I would really like to become more proficient in development, but I would first like to go to Australia for an extended period. And that I would really like to work for them after that. Quite a set of demands, but Nedap was totally fine with the idea. They told me to let them know when I was back and ready to begin the job!"
And so it happened. Kelly has been working at Nedap for 2 years now, where the culture is largely based on trust in people's own
responsibility and taking ownership. For example, days off are not recorded or tracked and there aren’t any fixed job descriptions. "That all sounds very nice, but in the beginning, I found it difficult to be sure whether I was doing enough and whether I was focusing my efforts on the right thing. I soon tended to work more than was maybe necessary. Now I'm used to it and dare to take space and time for myself. Without feeling guilty. It’s about taking responsibility for my work, but also for myself."
Variety is the spice of life
"Initially, I had very specific learning goals. My studies focused on user research and creativity, as well as technical implementation. But I wanted more depth. I took courses to develop myself further in areas such as front-end development. From there, I also moved into back-end development, which enabled me to use the knowledge and experience with other teams. This degree of variety makes me want more and more, because I continue to develop, and I have the opportunity to work with many different colleagues.”
noticed I need adventure from time to time and that I wanted to experience what it’s like to live and work somewhere else. Exploring Argentina had been high on my wish list for some time, so in close consultation with my team, I settled on a new, temporary work schedule and working remotely. Most of the major cities in Argentina are very suitable to work from, because they have good flex workplaces and fast internet connections. The 4 hours’ time difference with the Netherlands in wintertime is a good overlap of working hours. So I was able to work very well with my colleagues in Groenlo and discover the Argentine culture at the same time."
After 2 months, Kelly returned home, an experience richer. "The best thing I got out of it is the realisation that every day and the things we take for granted are actually very special. In addition, I got to know myself better and I got confirmation that I’d succeed in managing my life and work outside familiar surroundings. That gives me new energy and purpose, which I am happy to bring back to the team.”
Are you ready for your journey with us? Check nedap.com/careers/vacancies. Kell y
“I had quite a set of demands.”
COMBINING TEAMS AND TECHNOLOGY:
How a Medical Engineering graduate found
testing
Nikki Valckx discusses her transition to software test engineer and her current assignment, as well as her satisfaction in combining teams and technology for success.

I’m Nikki, a graduate in biomedical engineering now working as a software test engineer at ALTEN Nederland. My interest in exact sciences and medicine started at a young age, which led me to pursue a bachelor’s degree in Biomedical Engineering from TU Eindhoven in 2017 and then a master’s degree in Medical Engineering, specializing in Orthopaedic Biomechanics. There I could combine experimental work with mathematical simulations. After graduating in 2020, I attended a “Meet ALTEN” event where I learned about the role of a software tester and was intrigued by the idea of building bridges and critically assessing the quality of work. So, I applied at ALTEN and they offered me a position in the Test Masterclass to learn the basics of testing, obtain my ISTQB certification, and sharpen my knowledge with an interesting test case, all within six weeks.
TESTING ACTIVITIES
In my first year at ALTEN, I worked closely with an experienced tester on a cloud development assignment with a company specializing in high-tech print solutions. I mainly focused on testing activities, such as requirements and test automation, and was responsible for testing all new features and functionalities. After the experienced tester left for a new assignment, I took over and
became the scrum master as well. It was a nice new challenge that combined well with my other responsibilities.
DIFFERENT EXPERIENCE
Currently, I’m working on a new assignment with a company that makes pick-and-place machines, which is a completely different experience in terms of technology and work environment compared to the previous one in cloud and mobile app development. I no longer hold the official position of scrum master, but I still perform tasks associated with improving the processes in my new team. The work is challenging, since I get to work with different teams and applications, which keeps me interested and motivated.
As a software test engineer at ALTEN, I find a lot of satisfaction in my work, because I have a great deal of variety in my daily tasks. I focus on the quality of the software, while also providing added
value by asking critical questions that challenge the developers to improve their work. I maintain a critical mindset and actively seek answers to important questions such as: What are the specifications for this functionality? Who are the experts in this field? How can we test this properly? Does this functionality work as intended?
TEAM
I’m happy to be a part of the ALTEN team, as it is a dynamic company full of fellow consultants and with many opportunities for knowledge sharing, coaching, and training. With a people manager who guides you, using instruments like the career diamond, it provides an environment where I can grow into many different roles and discover what I like.
In terms of my future at ALTEN, I’m keen to keep developing as a tester and to further specialize in the process side. I enjoy collaborating with different stakeholders and finding solutions together in a team. I’ve learned that I can apply this skill set in all kinds of environments. Although some students ask me if I miss the biomedical domain, I feel satisfied in my role as a software test engineer and find joy in combining teams and technology to make them successful.
Nikki Valckx, software test engineer at ALTEN Nederland
her calling in software
ADVERTORIAL 58
‘People tend to think that your first job has to be perfect and that creates additional pressure’, says Koolhaas. ‘People starting out can also see on social media where everyone else is working, which also has an influence.’ This is why it’s so important to think about your motivations when making career choices, says Koolhaas. ‘Many people want to contribute towards sustainability. That’s logical and completely in line with our times. But is it really something that motivates you? Or do you just think that the world needs it? If a career choice doesn’t suit you, it can totally drain you.’
COACHING SESSION
During coaching sessions, the TU Delft Career Centre helps with these difficult choices. ‘The sessions help you to understand what you want and ensure that you’re better able to sell yourself to a company. The sessions are not only intended for students, but also for
TU alumni up to five years after they graduate.’ In these coaching sessions, Koolhaas or one of her colleagues deliberately avoids offering advice, she says. ‘When you give someone advice, you do it from your own perspective. That could be completely at odds with the other person’s situation at that time.’

OWN IDEAS
Instead, she coaches them and asks probing questions. ‘Then I might realise that someone wants a challenging job in a competitive environment, but also wants to go home at 5 PM’, she says. ‘So, I then ask: “Isn’t that rather contradictory?” And then people develop their own ideas. That’s much more valuable.’
RULING OUT OPTIONS
If you have absolutely no idea what kind of job you want, it can help to turn the question around, says Koolhaas. ‘Ask yourself: what do I definitely not want? Or try to draw up a list of ten to twelve
job choices based on your degree. Look at the skills involved and try to say something about them. This helps you to rule out options.’
Koolhaas: ‘The people closest to you can have certain expectations about your career path as well. If you ask someone you know for advice, choose a person who can be critical about you. If you show your motivation letter to your mother or brother, for example, you may not get that critical feedback. They know you personally and you may behave differently in a commercial, professional environment. So, think carefully about who will be able to give you honest, impartial advice.’
A COACHING SESSION IS FREE OF CHARGE UP TO A YEAR AFTER GRADUATION. AFTER THAT, YOU PAY €30 PER SESSION. THE OTHER UNIVERSITIES OF TECHNOLOGY ALSO OFFER HELP WITH CAREER CHOICES.
59 INTERVIEW TEXT ROB VAN DER WAL PHOTO OWN PICTURE CAREER SPECIAL 01/2023
‘If a career choice doesn’t suit you, it can totally drain you’
I
‘Many engineering students find it difficult to think about their own motivations’, says Marlies Koolhaas, career coach at the TU Delft Career Centre. ‘I talk to some people who see thousands of vacancies pass them by and completely freeze.’
Themajaar #100YPF

We hebben in Oss vier mijlpalen te vieren: 100 jaar Organon, 25 jaar MSD Biotech, 10 jaar Aspen API en 10 jaar Pivot Park. Van september 2022 tot oktober 2023 organiseren we daarom allerlei activiteiten. Zoals tentoonstellingen en een Outside Escape Route samen met museum Jan Cunen. Verder heeft Organon een Experience Center geopend en vinden de Figon Dutch Medicines Days in theater De Lievekamp plaats. Kom jij binnenkort eens farma-sfeer proeven in Oss, bijvoorbeeld op 19 september tijdens ons speciaal pre-Figon programma, met site visits en dinner tour?

Farmabedrijven in Oss bedienen het hele spectrum van de keten, van onderzoek, ontwikkeling en productie tot aan de distributie van geneesmiddelen. Het cluster werkt waar mogelijk samen, onderhoudt contacten met onderwijs en overheid, en is volop actief in allerlei lokale en (inter)nationale netwerken. Zo blijft Oss de bakermat voor allerlei ontwikkelingen, onder andere op het gebied van biotechnologie, nanotechnologie, oncologie en vrouwengezondheid. Kortom, het Osse farmacluster biedt een leven lang volop carrièremogelijkheden.
 Osse farmacluster
Osse farmacluster
In Oss vind je het beste van drie werelden: de stad, de kernen & het prachtige buitengebied. We bieden een goed woon- en leefklimaat waar je volop ruimte krijgt om je door te ontwikkelen en te ondernemen. Ervaringsdeskundige Nieké van Gils kan hier als voormalig TU Eindhovenstudent over meepraten. ‘In mijn stage en de eerste twee jaar hier bij Aspen API heb ik al veel facetten van het bedrijf mogen ervaren. En mijn werk op Moleneind is lekker dichtbij het station, het bruisende centrum, dat groter is dan ik dacht, en bij de campus van Pivot Park.’
Brabant barst van de energie! Samen komen we op nieuwe ideeën en creëren we oplossingen voor de uitdagingen van morgen. In Brabant vind je aanpakkers, avonturiers, denkers en doeners. Door ondernemerschap, innovatie en samenwerking worden de oplossingen voor problemen van de toekomst gevonden. Onder andere de vele patenten en de 4e plaats van Europese regio’s met een goed vestigingsklimaat onderstrepen dat Brabant een top kennis- en innovatieregio is waar je fantastisch kunt wonen, werken en leren.


In 2023 is het 100 jaar geleden dat in Oss de eerste medicijnen werden gemaakt. Een mijlpaal waar we trots op zijn en die we vieren met een themajaar.
De Osse farma staat aan de wieg van vele baanbrekende ontdekkingen en ook de komende 100 jaar willen we met onze innovatiekracht blijven bijdragen aan een wereldwijde goede gezondheid.
 #inBrabant
#inBrabant
100ypf.nl #100yearspharmafuture
Wonen & werken in Oss
Do great minds think alike? Three experts (TU Delft, government, and the business community) discuss a particular proposition. This time round, we talk with three TU Delft alumni Karien van Gennip, Minister of Social Affairs and Employment, Meike Salvadó, Director of Human Resources at Royal HaskoningDHV (now with Van Oord), and Nitesh Bharosa, Professor at GovTech and Diversity & Inclusion Officer at the Faculty of Technology, Policy and Management (TPM).
Inclusion in the workplace
WHEN IS THE WORKPLACE DIVERSE AND INCLUSIVE?
Van Gennip: ‘When people from all kinds of different backgrounds listen to and learn from each other.’
Salvadó: ‘It’s about diversity of thought, meaning that you have various perspectives, ideas, and approaches in your organisation.’
Bharosa: ‘You have diversity if people and ideas are not excluded. We are inclusive when we embrace these differences.’

WHY ARE DIVERSITY AND INCLUSION IMPORTANT?
Van Gennip: ‘If you work in an environment where you feel at home, then you feel better, perform better, are more creative, and get sick less frequently.’
Salvadó: ‘Diverse teams come up with the best solutions. All kinds of diversity contribute in this regard: sex, culture, religion, nationality, age, social class, and neurodiversity, to name just a few.’
Bharosa: ‘It’s the right thing to do, and it allows you to choose from a larger pool of people.’
HOW CAN ORGANISATIONS COMMUNICATE THE IMPORTANCE OF INCLUSION?
Van Gennip: ‘Include people around you who think differently than you and have different backgrounds.’
Salvadó: ‘Through inspiring leadership and role models at all levels in the organisations.’
TEXT SASKIA BONGER PHOTO TU DELFT INTERVIEW I 62
NITESH BHAROSA
Bharosa: ‘If you make the relationship between your diversity goals and your strategic goals clear, then everyone understands its importance.’
SHOULD YOU MAKE INCLUSION IN THE WORKPLACE COMPULSORY?
Van Gennip: ‘If you had asked me that same question 30 years ago, my answer would have been ‘no’, arguing that if you’re good, you’d make it anyway. By now, I’ve learned that it doesn’t always work that way. Women’s quota requirements do work. However, not everything is clearly measurable. Managers should take on the responsibility for making their own teams diverse.’

Salvadó: ‘Making things compulsory doesn’t work. People are naturally inclined to resist change, but if you make its importance clear to them, you can get them on board. You can also call people’s attention to their behaviour, for example by organising inclusive meetings where everyone feels safe and can have their say.’
Bharosa: ‘This is partly covered by article 1 of the Constitution, which deals with equal treatment. The real question
is what exactly you intend to enforce in addition, and how to measure it. I’m not saying you should never resort to enforcement, but I do think we can achieve much more by focusing on the benefits and necessity of diversity.’
IN YOUR EXPERIENCE, WHICH MEASURES WORK THE BEST?
Van Gennip: ‘The argument ‘We couldn’t find anyone’ is really outdated. Formulate your job vacancy announcement differently, publish it on a different date, present other applications, and formulate an inclusive standard. It can be effective if someone from a different team looks over your shoulder when you’re recruiting, since that person can come from a somewhat different organisational culture. Also make sure you include at least one ‘diversity applicant’ in the process. If they’re not chosen, they may make it through the door next time. And sometimes specify: for this position, we are choosing a woman or a person with a multicultural background.’
Salvadó: ‘It’s important to have a combination of measures that strengthen each other. You need to set a good example at the top, hire diverse people, show that inclusion is valuable in concrete examples, and make sure you encourage female talents in their career development. You also need to be proactive in creating awareness, working to encourage changes in behaviour, and pointing out the consequences of people’s behaviour. We have established a programme focused on inclusion, with various types of training and a ‘speak-up day’ which is a series
of videos in which people share their personal stories.’
Bharosa: ‘As a Diversity Officer, I have people around me who speak with people in the Faculty and listen to their issues. Based on their input, we discuss whether we need to update our plan for diversity and inclusion or enter into a two-way dialogue. After all, a plan like this needs to be translated effectively into practical action. So you need to take this plan to the people concerned, and not just have management look at it every now and then.’
WHO IS RESPONSIBLE FOR GETTING THESE SORTS OF MEASURES OFF THE GROUND?
Van Gennip: ‘Ultimately, employers are responsible for their own recruitment policy. The Government, however, can set laws and goals, for example on jobs for persons who are disadvantaged on the job market. And the Government can also make it clear to employers what it expects from them.’
Salvadó: ‘It starts at the top. HR can define measures and policies to create the right conditions, but good leadership remains essential. And ultimately
CAREER SPECIAL 01/2023 63
‘Ultimately everyone is responsible for creating an inclusive work environment’
MEIKE SALVADÓ
everyone is responsible for creating an inclusive work environment.’
Bharosa: ‘Within a faculty, the dean is responsible. For TU Delft as a whole, the Rector is responsible.’
HOW DO YOU CHANGE A CULTURE SO THAT EVERYONE CAN FEEL AT HOME?
Van Gennip: ‘Of course it takes some time, but that should not serve as an excuse for not changing. You need to have the mindset to want to change things. You can then make agreements with each other on the culture you wish to have and act accordingly.’
Salvadó: ‘Besides setting a good example from the top, we have defined the behaviours we expect from our employees. Processes and policy need to encourage these instead of frustrating them.’
Bharosa: ‘By proactively working with each other and creating positive experiences. There are a great many big issues that we can deal with more effectively if we invest more time and energy in better understanding each other.’
WHAT CAN DIFFERENT SECTORS LEARN FROM EACH OTHER?
Van Gennip: ‘That definitely needs to happen, as we are facing such major challenges as a society. The best scenario is when organisations sit down and share their challenges. Best practices are inspiring, but the best way to learn from each other is by daring to share stories about things that did not go well at all.’
Salvadó: ‘Challenges are never the same everywhere, which means that you can never simply copy solutions from others, but you can definitely learn from each other. That an inclusive culture is the best basis applies to all sectors. As a business community, we could work more effectively with government to create the proper collective conditions, for example by reducing wage differences or improving childcare conditions.’
Bharosa: ‘There is a kind of diversity industry of people who give training. They connect experiences and can encourage cross pollination. I am in contact with diversity officers at other universities. One of the things we do is discuss how we can best formulate more inclusive job vacancy announcements and job profiles.’
HOW LONG WILL IT TAKE BEFORE REAL DIVERSITY AND INCLUSION ARE FACTS OF LIFE?

Van Gennip: ‘At the present rate, it’ll
take another 125 years before there are as many women as men at the top, let alone persons with a bicultural background. I would therefore argue for a mandatory women’s quota. The time has come to set hard targets. I do think that much will change over the next decade, also because a large generation of women are almost at the top of their careers. If they too make more inclusive appointments, we will see a large shift in momentum.’
Salvadó: ‘We should not just sit back and wait. All of us are responsible. We need to make sure that everyone feels heard and appreciated, and feels safe and welcome. That will greatly accelerate matters, because it then becomes easier to recruit a diverse group of persons, give them appropriate career opportunities, and retain them.’
Bharosa: ‘These things take time, because we’re talking about major changes. If you force things too quickly, there’s a risk that people will feel they have not been heard and taken into account, and that will generate opposition. You need to really discuss matters with people, and that takes time, but I’m sure they will then realise that diversity and inclusion will only benefit the organisation. So I’m not all that impatient, even though I definitely don’t think we should just sit back and relax. I hope my children will end up living in a much more diverse society.’
64
‘I would argue for a mandatory women’s quota. The time has come to set hard targets’
KARIEN VAN GENNIP
FOLLOW A PATH OR SHAPE YOUR FUTURE?
In today’s world, change is a constant factor. Harnessing the positive potential of change is what Capgemini Engineering is all about. Innovation is our guiding principle - an inspiration that brings us to life and gives meaning to everything we do. At Capgemini Engineering, shape your career by working within a diverse collective of free thinkers, entrepeneurs and experts. Werkenbijcapgemini.nl
GET THE FUTURE YOU WANT










The initiative DutchDataBusters brings university and industry together by connecting Data Science and Computer Science students to businesses and providing them with guidance in solving concrete issues. This enables students to put their academic experience into practice while helping businesses overcome their growing demand for academic knowledge: a win-win situation.
Matchmaking between students and businesses
DutchDataBusters is an initiative by CodeNext21, a company that specializes in anomaly detection based on Machine Learning. TU/e alumnus Bram Cappers (picture) is one of the founders. It all started with the technology Cappers developed during his PhD. This technology became the foundation for ML21™, a platform used by CodeNext21 to look for deviations in data streams (aka ‘anomaly detection’). This involves analysing large amounts of data to find suspicious or deviating data. ‘It may concern huge Excel tables of financial transactions or patient information,’ Cappers says. ‘With all those data coming in, you have to determine very quickly if all of it’s okay.’ The smart technology is capable of comparing large amounts of data and, based on this, indicating when something deviates.

This way, you can analyse a very wide range of data and use the technology for different purposes. Another unique thing is that the system can tell you exactly why it thinks the data deviate.




‘Our platform provides a clear explanation of why the data deviate. Early on we noticed there’s a great need for this technology in industry, because businesses have all kinds of problems where anomaly detection would come in handy,’ Cappers says. ‘And the businesses often don’t have the required knowledge and time to solve these issues themselves.’
IMPROVE THE TIES
With this technology and knowledge in mind Cappers and his business partner Remco Eikhout, CEO of CodeNext21, started the initiative that matches students and businesses. ‘This creates collaborations that are of interest to both parties.’ As a non-profit organization, DutchDataBusters primarily aims to improve the ties between the university and industry. ‘But of course it’s also interesting for us to look through the eyes of the students to learn what’s going on at those businesses and acquire new insights that way,’ Cappers admits. DutchDataBusters facilitates the
collaboration in several ways. One important task is to safeguard the security of data. ‘For understandable reasons, businesses are often hesitant to share their data. An initiative like DutchDataBusters, led by experts with a lot of experience in data analysis, can help win the client’s trust. Businesses are more likely to collaborate with students if there’s a trustworthy intermediary that guarantees the secure processing of their data.’
Additionally, there are project supervisors to help students to find a suitable assignment, taking into account their interests, such as healthcare or sports. Because data analysis can be used in almost all fields, Cappers reiterates. ‘We look for a regional business that dovetails with the student’s interests and assist in drafting a concrete problem definition. The latter has to be both interesting to the business and meet the criteria of a graduation subject. We also offers students office space and assistance at the project level.’
67 STARTUP TEXT MARTINA SILBRNÍKOVÁ PHOTO CHRISTIAN HORZ CAREER SPECIAL 01/2023
S #5 DUTCHDATABUSTERS
How the engineering brains make EUV happen
Nano precision, 10 times faster than a Formula 1 car... Using a wavelength of just 13.5 nanometers (almost x-ray range), semiconductor giant ASML’s EUV lithography technology can do big things on a tiny scale. Take this for instance: by printing chip features with a resolution of just 13 nm, an EUV machine could print the entire Lord of the Rings Trilogy (481,000 words) on the side of an A4 sheet of paper...2,625 times!
Leading global semiconductor company ASML has developed its groundbreaking extreme ultraviolet (EUV) lithography technology over two decades, enabling its most advanced systems – and it’s all thanks to the vision, creativity, and persistence of its engineers.

Engineers as innovators
ASML is the only company in the world that owns this technology, and makes the machinery that produces physical chips out of silicon wafers. Bottom line is that the world’s top chipmakers wouldn’t be able to make the chips they do without ASML’s EUV technology. But it hasn’t come easy – it’s taken years of R&D research and billions of dollars.
But more importantly, it’s down to the talented human beings from a range of STEM fields at ASML that pull this off, enabled by a dynamic and challenging environment that allows their creativity to flourish, and to keep pushing the boundaries of what’s possible. For ASML’s engineers, it’s all just another day in the ‘office’ to be working with the extreme specifications needed to build machines to meet demands of a far-off future that can be hard to imagine.
Those adventures in deep technology demand the strong mindset and dogged determination of ASML’s engineers: to keep believing that you can make the impossible possible, to see setbacks as challenges, and to practice solution-oriented thinking. And it’s exactly this mindset that has laid the groundwork for ASML's EUV system – arguably one of the most complex machines ever made by human beings.
Over the two decades of EUV’s development, there’ve been many naysayers who predicted that ASML would fail to build a machine that worked, let alone meet all the specifications to make a success story of EUV. But ASML’s engineers pulled it off, finding solutions in creativity and the willingness to research and explore ideas anyway, no matter how out-of-the-box they seemed. They took calculated risks yet were confident in their beliefs. At ASML, they were supported and nurtured in their daily work, and were given the freedom to fail and experiment. This allowed them to continue to pioneer and stretch the limits of what’s physically possible – resulting in the birth of the EUV machine.
de Groot Director D&E Electronics Development EUV Scanner


 Optical Engineer
Hue SW Product Owner
Optical Engineer
Hue SW Product Owner
EUV
Brains behind
Axelle
Gijs ten Haaf
Harmke
Facts & Figures
Inquiring minds
Axelle: Realistically, these machines shouldn’t work! If you take each of their individual pieces into account, so many things could go wrong… Yet every feature is the result of brilliant minds all working together for many years to perfect the art of lithography.
Gijs: I like to understand how stuff works. At ASML I can do this on all levels: detailed physics, system level, and the system applications.
Harmke: I’m passionate about advancing technology through human ingenuity and teamwork. I still learn something new every day – both in technology and in how people work together, thrive, and develop themselves.
Contributing to society
Harmke: ASML’s EUV technology is pushing the limits in computing and memory. It’s helping to move progress forward and create solutions to some of society’s toughest problems. Think medical imaging for tracing cancer early; autonomous driving leading to fewer road accidents; robots that can help build a more sustainable world… These are all powered by lithography advancements. At the end of the day though, none of it can ever replace the human touch.
On ASML’s unique technology
Axelle: I’m proud to work at ASML and be part of the development of EUV – it’s a unique opportunity. But we have to be proactive in developing the next stage of technology, so we can keep pushing the boundaries of physics forward.
Gijs: I like the “can-do” mentality that made this technology happen. The development of the EUV source and scanners wouldn’t have been possible without the huge engineering efforts that made it happen.
Harmke: It’s fantastic that we’re now shipping EUV machines, while in 2014 an industry questionnaire still showed that about half of the semiconductor executives didn’t believe it could happen! It’s humbling and inspiring at the same time – we have a big responsibility towards the whole industry now.
Contributing to advancements in EUV


Gijs: EUV lithography machines are engineering masterpieces! For example, I work on the high-power CO2 laser you need to generate the plasma that emits EUV light. This laser is hugely powerful (tens of kW), and controlling parameters like beam positioning, pulse timing and shape are very tight. To make this work, you really need to get to grips with the physics in the laser system.
Axelle: One of the most complex parts of an EUV machine is the ‘source’, which generates the EUV light. To generate this light, a powerful CO2 laser hits the center of 50,000 tin droplets each second. Each of these droplets is only the size of a pixel! Part of our job as software engineers is to implement a motion control system to ensure shooting precision. We must also make sure the system follows the right setup sequences and is safe to use. In this way, ASML software development is a key part to giving life to a EUV source machine.
60+ Locations worldwide and 140 nationalities Global team of over 39,000+ €3.3 bn R&D expenses €21bn Annual net sales in 2022
Check out werkenbijETC.nl



























































































































































































































Or scan this QR-code for our current offer:

Challenging times demand challenging jobs.
At ETC you work on your own future and the future of clean energy. In Almelo, we produce centrifuges for uranium enrichment. That may sound tense, but it’s very hopeful. We play a crucial role in reducing CO2 emissions.













What is going to be your place in our team? Apply and let us know where your talents lie.
It doesn’t matter if you just received your Engineering, Communication, IT diploma or finished any other degree… we have the perfect job for you! So, what are you waiting for? Check out werkenbijETC.nl



















Challenging times demand challenging jobs. So, what are you waiting for?





Giving back freedom to musicians

Selim Haase has been involved with music since his childhood. He grew up in France and Morocco until his parents moved to Helmond. While studying at TU/e, he composed and produced music for more and more Dutch artists. When he accompanied one of his clients to a gig, he noticed that there were only rap songs on the setlist. Haase: ‘When I asked him why he skipped all the songs with vocals, the answer was that he prefers not to perform those songs live, because he can’t use Auto-Tune on stage. And then the songs don’t sound the way they’re meant to.’
What is Auto-Tune? You can think of it as an audio processor that measures and changes the pitch in vocal lines and instrumental music. It was invented as a correction tool in a studio setting. ‘As computers got faster and faster at the beginning of this century, that system was automated,’ Haase explains. ‘The incoming signal of a vocal note is analyzed. The user can then choose to tune that pitch to a particular key. Auto-Tune looks at which notes are closest to that, so it never sounds out of tune.’
According to Daniel Grifiths of the English music magazine Future Music, the effect is now used in 99 percent of the songs. So, while Auto-Tune dominates the music industry, using this effect during a live performance is a major obstacle for the artist. Haase looked for a solution during his master’s project. Now he is CEO of Boldwav, a start-up that develops an add-on for microphones so that artists control their audio settings themselves during a live performance. In the controlled environment of a studio, the effect is very easy to use, but live it is anything but. Auto-Tune is key-sensitive, each song requires a different setting. More importantly, there is no middle ground. ‘If you use Auto-Tune correctly, listeners often don’t even notice. But, if it goes wrong, it’s the worst thing ever, because then a song immediately sounds as out of tune as a door.’
Boldwav’s add-on can be clipped onto a microphone (see photo). Haase cannot say what is incorporated into the hardware of this small device; he recently filed a patent for the technology. The entrepreneur wants to keep the add-on itself as simple as possible because the most important thing is that the device is easy to use. ‘We started out with a lot more features, but we deleted more and more of those. Artists want to be concerned as little as possible with peripheral issues and be able to focus on the performance and their audience.’
Boldwav has three functions: the artist can scroll between presets and select them on a small screen, turn the AutoTune on and off, and it has a ‘lock’ function on it, so an artist doesn’t accidentally change the settings.

Musician Selim Haase, a former TU/e student Industrial Design, is CEO of Boldwav, a start-up that develops an add-on for microphones so that artists control their audio settings themselves during a live performance.
BOLDWAV START-UP TEXT AAFKE EPPINGA PHOTO OWN PICTURES S 71 #6 CAREER SPECIAL 01/2023
Continuously improving our total rewards & benefits package
As a fresh MA graduate in Business Administration from Radboud University Nijmegen, the world was open for Hananja Monster. Though she didn’t hesitate to accept a role as trainee at Kramp Varsseveld. The story at Kramp started 7.5 years ago and is continuing. Currently, Hananja works as a Global Continuous Improvement Lead. She works at the Head office in Varsseveld but travels all over Europe.

‘Time flies where you are having fun, they say. This sentence absolutely applies to me when looking at my career at Kramp. Starting a role as an international trainee was the best career start I could have wished for. At that time, I had a few job offers I could choose from but the combination of the international scope, the wide range of possibilities for training AND the 37 holidays (��) made me decide to choose for Kramp!’
BENEFITS AS PART OF AN OPEN CULTURE
It’s not so common for companies to offer a wide range of (in-house) trainings to employees but Kramp does. ‘I am one of many colleagues who often makes use of the possibility to follow training and courses. An example is a coaching training I always wanted to follow. At Kramp you really feel that you matter as an employee. Most managers are always stimulating you to develop yourself by selecting the right trainings and courses.’
‘I am not only developing myself by following courses, but I am also developing by collaborating with my international colleagues. I feel lucky to know at least a few people from each of our

international offices (and we have 25 offices in Europe!). Of course, it helps that an important part of my role is giving training to people in Continuous Improvement. In this case I get to know a lot of people and build a network all over Europe. In fact, I just came back from a 3-day business trip to Denmark.’
IMPORTANT SECONDARY BENEFITS FOR ME PERSONALLY
It’s not so new that people also value good secondary benefits. Kramp has a global compensation and benefits team who are continuously improving the benefits and keep ahead of the labor market.

‘Personally, I love the number of vacation days we have! 37 days (except public holidays) is really a lot! In the beginning I didn’t know how to use them all, so instead I converted part of the days into extra salary. Nowadays, I value work life balance a bit more and I can easily spend my 37 vacation days travelling, renovating our campervan, and rebuilding our recently bought house. Saying that, as a Kramp employee I receive a good discount on the products in our web shop, so I buy lots of tools and spare parts with a nice discount.’
Besides this, our flexible working policy helps me performing my hobbies. If I want to spend a random hour going for a run, I can easily compensate for these hours at a different time of the day. The fact that we get a lot of freedom, development opportunities and responsibilities at Kramp makes me feel valued.
INTERESTED IN WORKING AT KRAMP? PLEASE VISIT OUR CAREER PAGE AND GET IN TOUCH WITH OUR RECRUITMENT TEAM: CAREERATKRAMP.COM E: RECRUITMENT@KRAMP.COM
ADVERTORIAL 72
CAREER LEOPARD
My career is, as of yet, not something I have spent significant amounts of time on. After all, it’ll be a few more years before I’ll even come close to entering the job market. But on the other hand, I have some time stressing over it.
You see, the job market, as projected towards students, seems tailored towards career tigers. A ‘career tiger’ is a Dutch term for someone who is very focused on their career; on making it as far as possible. This kind of person will pour all of their waking hours into their career; they’ll cold-call recruiters before they get the chance to do it to them, go to all the career fairs they can get tickets to, network to their hearts’ content — just to get that perfect job in the burnout factory they desire.

Maybe this vibe is even best exemplified by the very magazine you’re now reading. Just have a look at it: lots of stories, tips and tricks from ‘entrepreneurs’, alumni and recruiters, all to get you hyped up for the process. And most of it is sprinkled with hype-y but hollow marketing language. All of this just seems daunting and exhausting from a distance — stressful and off-putting even. If I’ve learned one thing in the past couple of years is that I don’t want to pour all of my waking moments into my career. I don’t want to jump through a million hoops just to get marginally ahead of everyone else, let alone land that ‘perfect’ job — whatever that might mean. I’m just not a career tiger.
Instead, you might call me a ‘career leopard’. In Dutch, if you have no idea what a leopard is you might think I was talking about a lazy horse. That checks out; after all, I clearly don’t want to put in the effort to get that job — I just put my hooves into the sand just to be difficult. Right?
But remember, a leopard is still a strong, albeit solitary animal. Some cultures consider it a better hunter than the lion; others regard it as the symbol of leadership. Career leopards, in context of this crumbling metaphor, are just as highly skilled as all those career tigers, but instead of being loud at the forefront, don’t want to wear their skills and motivations on their sleeve; instead of jumping at every opportunity they can get they are more careful with what they accept.
It’s definitely not like I don’t want to put in the effort. I just don’t wish to participate in the cargo cult that, at times, can be the job market. I just want to make my career on my own terms, and I think I’m far from alone. Even though I might be a leopard, I’m not some recruiter’s circus animal.
COLUMN C #2 73 CAREER SPECIAL 01/2023
Niels ter Meer, Student of Mechanical Engineering at University of Twente
Dancing along at Mosa Meat
If you want to understand the UT alumnus , just search for the ‘Shirtless Dancing Guy’ video on YouTube. The video shows a man dancing at a festival, a bit silly and all by himself. Until, after a few awkward seconds, a second festival-goer starts dancing along. He then calls his friends over to join them and before long, a whole crowd is partying to the music. But how is this
translated into the business world? In this case, the ‘Shirtless Dancing Guy’ is an entrepreneur or inventor with a plan that seems insane, until someone else comes along who believes in the story and starts ‘dancing along’.
Van de Rijdt does not think of himself as the first shirtless festival-goer, but rather as the second dancer. This is exactly
the role he fulfils at Dutch company Mosa Meat. In 2013, professor Mark Post and food expert Peter Verstrate succeeded in creating the first cultured meat burger. When Van de Rijdt heard about the project, he was immediately enthusiastic. ‘I offered to help. I did so for a year and a half, from the train and in the evenings, alongside my regular job.’

CULTURED MEAT
Van de Rijdt has now been working at Mosa Meat for many years. The Limburgbased company uses one minuscule piece of meat from a live cow to make a hamburger via cell multiplication. This means it is real meat, but no animals have to be slaughtered to make it. In recent years, an entire industry has emerged in this ‘cellular
A #4
The career of Tim van de Rijdt (40) is anything but run-of-the-mill. After working for Newcom and Google, he is now Chief Marketing Officer at cultured meat company Mosa Meat. ‘We’re not counting on any mass consumer behaviour change; that’s why we cultivate meat.’
TIM VAN DE RIJDT
ALUMNUS UNIVERSITY OF TWENTE
74 TEXT
CHIEF MARKETING OFFICER AT MOSA MEAT
JELLE POSTHUMA PHOTOS CHRISTIAAN KROUWELS ALUMNUS
agriculture’, producing meat, fish and leather. Currently, the main challenge is to produce high-quality meat, on a large scale and at a reasonable price, explains the alumnus. Mind you, the cost of the first piece of cultured meat in 2013 was 250 thousand euros. On top of that, Mosa Meat’s product should have the smallest possible ecological footprint.

PETRI DISH
Compared to slaughtered beef, cultured beef requires 95 percent less agricultural land, generates 93 percent less air pollution and uses 78 percent less water, figures from research firm CE Delft show. An additional benefit: consumers can continue to eat meat. ‘With our technology, we’re not counting on any mass consumer behavioural change; not everyone will become vegan of their own free will. That’s why Mosa Meat makes the same meat, but in a sustainable
way.’ But how to turn this into a commercial success? Therein lies a major task for the Chief Marketing Officer. His job is threefold. ‘First, I look at where we can offer our meat. I also maintain contact with potential buyers, such as supermarket chains or restaurant chefs, i.e. the ‘sales side’. Finally, I try to draw attention to the product and define the image.’
TWENTE
Van de Rijdt learnt his first skills in communication and marketing in Enschede. In 2000, he arrived at the Twente campus to study Applied Communication Science (TCW). ‘I’m a true generalist at heart and was thrilled to have found a broad programme in TCW. Plus, the campus was great; a kind of Center Parcs where I could also study.’ Van de Rijdt was, in his own words, an ‘academic late bloomer’. ‘It was only at the end of my studies that I realised that
science allows you to add something to what we already know. That’s when the penny dropped for me.’ Even more important was his meeting with Neil van der Veer, founder of Newcom. The research company was part of the TCW programme back then, and specialised in online research, rather than paper surveys. Many TCW students were able to find work at the thriving Newcom, just as Van de Rijdt.
Although Van de Rijdt was not looking for another job, a new opportunity presented itself in 2008. He took on various roles within Google. The UT
alumnus felt right at home working at Google, but as time passed, he felt the urge to pay more attention to ‘what the world needs’. With Mosa Meat, it is all about sustainable meat. ‘But the movement is much broader than that. Consumer behaviour is not changing fast enough and governments are slow to act. This new movement, call it ‘hacking capitalism’, is aimed at solving problems independently of the authorities and consumer behaviour by means of technology. This development is desperately needed, which is why I started dancing along at Mosa Meat.’
‘Worldwide meat consumption is still growing’
75 CAREER SPECIAL 01/2023
what fires you up and get noticed for it’
Aukje Doornbos, Ellis ten Dam, Sandra Heuts are three topflight alumnae from TU/e that have earned their stripes. In their capacity as female role models they are keen to pass on the lessons they’ve learned to the upcoming generation of women in engineering. A conversation about hurdles, humor, and the importance of sponsors who help you move ahead in your career.
‘You don’t decide whether to become a role model, you are a role model. Once you realize that and start thinking about how you can help and what you can pass on, you can actively inhabit the role,’ says Sandra Heuts, managing partner of Risk Advisory at Deloitte. Heuts was the first woman to join the management team, so she didn’t have many female role models. ‘Luckily, I had a fantastic boss who believed in me and let me do things my own way.’
This emphasis on the importance of female role models is endorsed by Aukje Doornbos, managing director of Covestro Netherlands. ‘I joined DSM in 2004 and women in higher positions there became my role models. These women were happy to have the younger generation come to them for advice. About things like how to combine having a career with children. Practical matters that men never have to consider but that as women we do.

TEXT BRIGIT SPAN PHOTO LORAINE BODEWES INTERVIEW I 76
‘Discover
AUKJE DOORNBOS IS MANAGING DIRECTOR OF COVESTRO NETHERLANDS, A GERMAN CHEMICAL COMPANY WITH ITS ROOTS IN BAYER. THE COMPANY PRODUCES HIGH-TECH PLASTICS FOR USE IN INSULATION MATERIALS, ELECTRIC CARS, CELL PHONES AND TVS, AND IT PRODUCES COATINGS FOR, AMONG OTHER THINGS, SOLAR PANELS. SHE STUDIED CHEMISTRY & CHEMICAL ENGINEERING AT TU/E.


COURAGE
Ellis ten Dam, commercial director of Buildings at Royal HaskoningDHV, adds: ‘A sponsor can also be someone from outside your own organization.’ For her, an important sponsor was the director who brought her into Royal HaskoningDHV. ‘At the time I was the first woman, but he had the courage to hire me. His words were: “You’re exactly who I want because you aren’t the same”.’ Ten Dam stresses that you don’t need to limit yourself to just one sponsor. ‘See what you need, and go shopping.’
Ten Dam advises seeking a sponsor connected with whatever it is that fires you up. ‘If you’re passionate about something, you’ll be able to shine, and that gets noticed. Be bold, approach people who may be able to help you move forward.’
WOMEN IN A MAN’S WORLD
When this question is put to them, a great many women refuse to answer. “It’s not a question you’d ask a man, is it?” Me, on the other hand, I’m all in favor of talking about it because then other women get an idea of how it can be done.’
‘It feels good and it’s inspiring, especially during your first ten years, a period of perpetual uncertainty about everything you’re encountering, to be able to learn from other women who’ve already cleared these hurdles.’ My role models were really valuable, says Doornbos. ‘But the people responsible for my being where I am now were often men - my sponsors. They let me show what I’m capable of when I do things my way.’
To nudge them in the right direction, Heuts regularly calls up her protégés. ‘I see it as an informal network of women helping each other move ahead. As a sponsor I can bring something to that network. I can give advice, or put two parties in touch with one another, perhaps to pave the way for them to talk. There’s more to this network than just climbing the career ladder. It’s all about connecting, discovering where your passion lies,’ says Heuts. ‘There’s no need to brag either; good sponsors can spot your ability,’ adds Doornbos.
SPONSORS IN ALL PHASES
Role models and sponsors can be useful at various times, including at university. ‘As a graduating student, I was given a position on the KiVi board (Royal Netherlands Society of Engineers) that I later handed on to another female student,’ says Ten Dam. Heuts was a student assistant and was asked a lot of questions about the position by other students. ‘So I was already a role model when I was still studying.’
But sponsors don’t just fall into your lap, as Doornbos knows. ‘You have to put yourself out there, be proactive.’
All three are working women in a man’s world, but they are all unfazed. They know from experience that it pays to be well armed with humor, a healthy sense of perspective, and good preparation. ‘This men versus women stance sometimes gets my goat,’ says Ten Dam. ‘I grew up in a family of boys and when I joined the company I was the only woman, but that’s never really bothered
ELLIS TEN DAM IS COMMERCIAL DIRECTOR OF BUILDINGS AT ROYAL HASKONINGDHV, AN ENGINEERING CONSULTANCY AND PROJECT MANAGEMENT SPECIALIST. ROYAL HASKONING HAS OFFICES IN MORE THAN THIRTY COUNTRIES AND MORE THAN 6,000 EMPLOYEES. SHE STUDIED REAL ESTATE MANAGEMENT AT TU/E.
CAREER SPECIAL 01/2023 77
me. We’re all on the same side, after all. Having people come at things from different perspectives only makes an organization better. It’s enriching. And gender balance isn’t the sum total of diversity either,’ she argues.
‘I completely agree,’ says Doornbos. ‘But that’s not to say that as the only woman or, say, Indian, you might not feel a little uncertain. Rest assured, there are things you can do to boost your confidence and shine. Ensure that you aren’t underdressed. Dress in a way that makes you feel powerful and sure of yourself. ‘
Doornbos has encountered unconscious prejudice regularly throughout her career. But she approaches these situations with humor. ‘One day I was sitting in my office - I had just become business manager at DSM - when a man walked in and asked me if I could check when the business manager would have time to see him. “I’ll have a look in a minute,” I replied. I was angry and amazed, but I also realized that he hadn’t walked into my office with the aim of upsetting me. He fitted what he saw into his worldview and acted accordingly.’
CULTURAL LENS
The story Doornbos tells elicits a smile from Heuts. ‘Yes, I’ve experienced it too in my work, but I’ve never thought there was any nastiness intended. It’s to do with the lens through which a person looks at the world, not only at women but at other cultures too.’
Ten Dam says that she too is very aware of her positioning in situations, a business deal for example. ‘I don’t want them walking all over me, so I come well prepared. I distribute the roles and tasks in advance. That keeps me on my toes.’
Sometimes the positioning game is a matter of how close to the center of power you are. Doornbos was working at DSM when it was acquired by Covestro. ‘I was among those who moved across. Not only was I the only woman, but I was also ten to fifteen years younger than most of the men. I asked my coach what I could do to claim my ground. ‘Arrive at a meeting an hour earlier than everyone else and use your jacket and bag to claim your place. Then, when the boss arrives, you can reassess the best place to sit.’
LEADERSHIP
All three manage their staff intuitively, and each brings her own personal touch to the task. Doornbos: ‘I like to be true to myself, to combine rationality and feelings, and be bold enough to trust both.’
Ten Dam sees herself as a connective leader. ‘I aim to bring the various perspectives to the table and connect them, both the people and the content. I look at what’s happening beyond the company, and at what we need to be responsive to when we act, informed by the broader objective in the back of my mind. As soon as I have a good team that’s up and running, I can let go.’
SANDRA HEUTS IS MANAGING PARTNER OF RISK ADVISORY AT DELOITTE, ONE OF THE LARGEST PROVIDERS OF PROFESSIONAL SERVICES IN CONSULTANCY AND ACCOUNTANCY, AND ADVISORY SERVICES RELATED TO TAX, RISK AND FINANCE. SHE STUDIED MECHANICAL ENGINEERING AT TU/E.

Heuts describes herself as a connector with vision. ‘I work with my head and my heart. People see me as someone who knows how to get a team running smoothly, all its members working together towards a common goal. With my enthusiasm I can get people on board with my ideas. Keeping the dialogue going, that’s something I really value.’
All three women decided that they wanted to strengthen their ties with TU/e, their alma mater. They want to act for female students as the role models they already are. Heuts: ‘I have a lot of experience of connecting knowledge with trade and industry. Now that the valorization of research projects is on the increase at the university, I can play a useful role.’ Doornbos and Ten Dam are also making themselves available to bat ideas around with female students.
‘There’s more than just climbing the career ladder. It’s all about connecting, discovering where your passion lies’
78
Do you want te become part of NEDCON?
My name is Michael Schmitz and I have been a Sales Engineer at NEDCON for almost 3 years. I am 29 years old and one of the German colleagues at NEDCON. I live just across the border, in Bocholt.As a Sales Engineer, I am involved in the sales phase of projects. I support the Account Managers in the field by calculating prices, making drawings, defining the technique while taking into account the customer’s wishes. I find this particularly interesting because I am between sales and engineering. I take the customer’s questions and see which technique can be applied. I work closely with our engineering department, which is a great challenge for me. After all, I get to deal with both sides of the coin!
My name is Michael Schmitz and I have been a Sales Engineer at NEDCON for almost 3 years. I am 29 years old and one of the German colleagues at NEDCON. I live just across the border, in Bocholt.As a Sales Engineer, I am involved in the sales phase of projects. I support the Account Managers in the field by calculating prices, making drawings, defining the technique while taking into account the customer’s wishes. I find this particularly interesting because I am between sales and engineering. I take the customer’s questions and see which technique can be applied. I work closely with our engineering department, which is a great challenge for me. After all, I get to deal with both sides of the coin!

What does the department you work in look like?
I am working in the Key Accounts/Reseller department, which has quite a big office on the top floor at NEDCON. We are with around 30 colleagues up there, if everyone is present. Every age is represented among the colleagues. Some have been with NEDCON for around 40 years, while others have only been there for a few weeks. That always makes the exchange among each other interesting.
What is a typical NEDCON employee?
In my opinion, a typical NEDCON employee is someone who is open to communicating with people and who is not afraid to ask questions. Someone who is always curious.
NEDCON has its own company restaurant. Is this an important place for you in the office?
I particularly like the fact that at NEDCON you can have lunch with your colleagues during the lunch break. That brings you closer to your colleagues and gives time for private conversations, also with colleagues from other departments. I find that very pleasant.
VACANCIES:
· Project Engineer
· Sales Engineer
· R&D Engineer
What is your greatest memory of your time at NEDCON to date?
I would like to mention two events here: Firstly, the 50th anniversary of NEDCON, what a party that was! The celebrations at NEDCON are always unique. Secondly, a business trip to Sweden with three of my colleagues. Here I was able to gain so much experience in terms of sales and customer relations. I really enjoyed it.
What I like most about working at NEDCON is...
There is a very open atmosphere here, which I like very much about working in the Netherlands. People are open to other cultures, and there are short processes and lines. There is a very flat hierarchy here. Personally, I like that very much and I think that all of the above also characterizes NEDCON’s philosophy.
Why do you recommend others to start working at NEDCON?
At NEDCON, the focus is on the employee. There are many small attentions that make everyone feel valuable and every employee in return gives their best back to NEDCON. A success story is being written here!
NEDCON
NEDCON is an organization with over 500 employees. We produce steel storage systems. We develop, test and manufacture these systems entirely in-house. Our products are sold and installed in warehouses of (international) organizations all over the world, including well-known mail-order companies, webshops and supermarkets. In addition to our head office in the Netherlands, we have branches in various European countries and the United States.

WHY NEDCON?
• Lots of freedom
• Good work-life balance
• Challenging and varied
• Own company restaurant where you can have lunch at cost price
• Working for clients such as Zalando, DHL, Albert Heijn, Philips, Hema and other A-brands worldwide
CONTACT
careers.nedcon.com recruitment@nedcon.com
JE HOEFT GEEN MILITAIR TE ZIJN OM BIJ DEFENSIE TE WERKEN
Dat kan ook als burgermedewerker. Je draagt dan geen uniform, maar je werkt wel vanuit je eigen vakgebied aan vrede en veiligheid. Dat doe je schouder aan schouder met militairen. Zo maak je jouw specialisme nog specialer.
WAT IS DWS&B?
Directie Wapensystemen en Bedrijven (DWS&B) is onderdeel van het Commando Materieel en IT (COMMIT). Een plek met inhoudelijk interessant werk en waar je iets kunt betekenen voor Nederland en zijn bondgenoten. COMMIT levert de krijgsmacht hoogwaardig materieel en IT. DWS&B draagt hieraan bij met kennis en expertise op het gebied van inkoop en instandhouding van materieel, zodat wapensystemen en mensen doelgericht en veilig kunnen opereren op topniveau. Collega’s Rick van der Gouw en Maria Viegers vertellen je meer.
WERKEN MET NIEUWE TECHNOLOGIE
Rick van der Gouw werkt twee jaar als sr. medewerker Techniek bij Grondgebonden Wapen Systemen (GWS) van DWS&B.
“Na mijn studie Automotive en master Mechanical Engineering zocht ik een baan waarbij ik met de nieuwste technologieën kon werken én deze kon toepassen. Zo kwam ik bij GWS terecht. Hier ben ik verantwoordelijk voor de technische staat van de wielvoertuigen. Ik voer updates uit en doe modificaties zodat de voertuigen veilig te gebruiken zijn.

Wat ik te gek vind, is het toepassen van nieuwe technologieën op defensievoertuigen. De E-Fennek is hiervan een goed voorbeeld: een elektrische variant van het Fennek-verkenningsvoertuig.
Binnen dit project onderzoeken we waar e-techniek beter scoort dan conventionele techniek en waar verbetering nodig is. Gaaf is dat het voertuig ook echt rijdt en in de praktijk wordt getest.
Ook is de E-Fennek een mooi platform om volgende technologieprojecten op uit te voeren. Zo ben ik bezig om een turbinegenerator als range extender op de E-Fennek te plaatsen. Daarmee vergroten we niet alleen de actieradius, maar kijken we ook wat nodig is voor zo’n integratie op een hoog-voltage elektrisch voertuig. De communicatie tussen het voertuig en de range extender is daarvan een onderdeel, maar bijvoorbeeld ook de luchtstroom van de generator. Leuk is dat we met onze collega’s van het AMEC een 3D-scanner hebben gebruikt om de hele motorruimte en het motordek in te scannen. Hiermee hebben we snel een 3D-model van dit voertuig gemaakt zonder dit uitgebreid in software te modelleren.”
werkenbijdefensie.nl/burgermedewerker

ENERGIE KRIJGEN VAN ONDERZOEK ÉN PRAKTIJK
Maria Viegers is Naval Systems Integrator bij de afdeling Maritieme Systemen (AMS) van DWS&B. ‘’Als millennial wil ik bijdragen aan belangrijke maatschappelijke ontwikkelingen. Ik kwam in contact met Defensie via een vacature voor Naval Systems Integrator bij de Sectie Technologie Integratie van de AMS. Ik vind het interessant om te onderzoeken, maar krijg ook energie als ik de resultaten terugzie in de praktijk. Enerzijds werk ik aan studies naar nieuwe technologieën, anderzijds ben ik bezig met instandhouding, verbetering en ontwikkeling van toekomstige schepen.

Een voorbeeld waaraan ik werk is het nieuwbouwproject van het Anti-Submarine Warfare Frigate (ASWF). In de toekomst gaan schepen met kleinere bemanning varen. Om hen te ondersteunen is er meer automatisering nodig. Daarnaast ligt het accent steeds meer op informatiegestuurd optreden. Hierin hou ik mij bezig met de aanbesteding van automatiseringssystemen voor voortstuwing, energieopwekking en calamiteitenbestrijding.
Ik ben een paar keer meegevaren om het leven aan boord te ervaren. Zo krijg ik nuttige input wat ik meeneem in mijn werk. Het mooie is dat je bij ons zelf invulling kunt geven aan de onderwerpen waaraan jij graag wilt werken. Je hebt hier contact met grote technische partijen. De mensen bij Defensie zijn vriendelijk en behulpzaam. Er is veel diversiteit en ik heb veel vrouwelijke collega’s, erg leuk in een ogenschijnlijke mannenwereld. Kortom, alle ruimte voor persoonlijke groei en een prima werk-privébalans.’’
Ontmoet DWS&B
Benieuwd welke rollen er zijn binnen DWS&B? Of wil je praten met onze recruiters?
Scan dan de QR-code en meld je aan voor een kennismakingsevent op donderdag 6 juli op de Kromhoutkazerne Utrecht. werkenbijdefensie.nl/techniekbijCOMMIT
Thomas Boersma EY Senior Consultant
Thomas Boersma EY Senior Consultant Data Engineering
 Thomas Boersma
Rabab Laarabi EY Manager
Thomas Boersma
Rabab Laarabi EY Manager
Cybersecurity
EY Senior Consultant Data Engineering

What does EY and your job mean to you?
Data Engineering
How would you explain EY and the field you work in?
How would you explain EY and the field you work in?
How would you explain EY and the field you work in?
Currently, I am part of a project team of 10 colleagues, tackling a complex problem for a client spanning multiple countries. For this client, “I also had the opportunity to fly out to Rome and present our implemented solution to our client with the team.” Sure, the work can be challenging at times, but the sense of accomplishment when you meet a deadline or exceed expectations is second to none. Our team in the Netherlands consists of around 70 data scientists & engineers and are from various backgrounds, both technically and culturally, which results in a team with broad expertise, a pleasant atmosphere and great drinks on the Friday.
everything runs smoothly.Throughout the day, I’m always available to answer any questions my colleagues have and review pull requests when needed. It’s a busy and challenging job, but I love it!
Currently, I am part of a project team of 10 colleagues, tackling a complex problem for a client spanning multiple countries. For this client, “I also had the opportunity to fly out to Rome and present our implemented solution to our client with the team.” Sure, the work can be challenging at times, but the sense of accomplishment when you meet a deadline or exceed expectations is second to none. Our team in the Netherlands consists of around 70 data scientists & engineers and are from various backgrounds, both technically and culturally, which results in a team with broad expertise, a pleasant atmosphere and great drinks on the Friday.
everything runs smoothly.Throughout the day, I’m always available to answer any questions my colleagues have and review pull requests when needed. It’s a busy and challenging job, but I love it!
Currently, I am part of a project team of 10 colleagues, tackling a complex problem for a client spanning multiple countries. For this client, “I also had the opportunity to fly out to Rome and present our implemented solution to our client with the team.” Sure, the work can be challenging at times, but the sense of accomplishment when you meet a deadline or exceed expectations is second to none. Our team in the Netherlands consists of around 70 data scientists & engineers and are from various backgrounds, both technically and culturally, which results in a team with broad expertise, a pleasant atmosphere and great drinks on the Friday.
What’s your day to day as a Data Engineer?
What’s your day to day as a Data Engineer?
everything runs smoothly.Throughout the day, I’m always available to answer any questions my colleagues have and review pull requests when needed. It’s a busy and challenging job, but I love it!
develop a deep understanding of the unique challenges that different organizations face and tailor my approach accordingly. At the end of the day, this is what I truly find rewarding, to work in an industry where my contributions can have a significant impact on my clients’ success.
Tell us something about yourself and how you got into Data?
Tell us something about yourself and how you got into Data?
Tell us something about yourself and how you got into Data?
What’s your day to day as a Data Engineer?
Having worked at EY for the past 5 and half years, I can say that it is an excellent work culture that fosters creativity, innovation, and collaboration. EY has a strong commitment to investing in its employees’ professional development and offers numerous opportunities for growth. As a cybersecurity manager within the financial services industry, I have to have a deep understanding of the financial services industry, the associated regulatory requirements, as well as expertise in cybersecurity domains and best practices. Overall, EY has offered me with the support, resources and opportunities that I need to succeed in my career and I am proud to be part of such a dynamic and forward-thinking organization.
At the age of 14, I developed an interest in programming because I was fascinated by coding and enjoyed creating things from scratch. Naturally, this led me to pursue a bachelor’s degree in Software Engineering with a minor in Data Science. Although my initial career path was focused on software engineering, I became interested in big data after reading some books about it. Consequently, I transitioned into a role as a Data Engineer, and found the transition to be relatively smooth - ”with a bit of techsavvy knowhow and if you relish a good challenge, anyone can learn the ropes quite quickly.”
complete data lakehouse from scratch. To ensure the project is a success, we’re using Azure Purview to create a comprehensive data lineage that visually tracks every source and transformation used in a given dataset. So, it is not only die hard data cleansing but there is also room to use other techniques like software and platform engineering.
complete data lakehouse from scratch. To ensure the project is a success, we’re using Azure Purview to create a comprehensive data lineage that visually tracks every source and transformation used in a given dataset. So, it is not only die hard data cleansing but there is also room to use other techniques like software and platform engineering.
Every day is different, and we’re always helping out other teams. But let me try to walk you through what a day looks like. First, I start off with our daily stand up where we catch up on what each team member worked on the previous day and assign new tasks for the day ahead. After that, I usually have a meeting with clients to discuss various data sources and validate the data while ensuring we’re following the right business rules. Armed with this information, we dive into building pipelines and scripts to make sure
Every day is different, and we’re always helping out other teams. But let me try to walk you through what a day looks like. First, I start off with our daily stand up where we catch up on what each team member worked on the previous day and assign new tasks for the day ahead. After that, I usually have a meeting with clients to discuss various data sources and validate the data while ensuring we’re following the right business rules. Armed with this information, we dive into building pipelines and scripts to make sure
At the age of 14, I developed an interest in programming because I was fascinated by coding and enjoyed creating things from scratch. Naturally, this led me to pursue a bachelor’s degree in Software Engineering with a minor in Data Science. Although my initial career path was focused on software engineering, I became interested in big data after reading some books about it. Consequently, I transitioned into a role as a Data Engineer, and found the transition to be relatively smooth - ”with a bit of techsavvy knowhow and if you relish a good challenge, anyone can learn the ropes quite quickly.”
What does a typical day as Cyber Security manager look like?
Every day is different, and we’re always helping out other teams. But let me try to walk you through what a day looks like. First, I start off with our daily stand up where we catch up on what each team member worked on the previous day and assign new tasks for the day ahead. After that, I usually have a meeting with clients to discuss various data sources and validate the data while ensuring we’re following the right business rules. Armed with this information, we dive into building pipelines and scripts to make sure
At the age of 14, I developed an interest in programming because I was fascinated by coding and enjoyed creating things from scratch. Naturally, this led me to pursue a bachelor’s degree in Software Engineering with a minor in Data Science. Although my initial career path was focused on software engineering, I became interested in big data after reading some books about it. Consequently, I transitioned into a role as a Data Engineer, and found the transition to be relatively smooth - ”with a bit of techsavvy knowhow and if you relish a good challenge, anyone can
complete data lakehouse from scratch. To ensure the project is a success, we’re using Azure Purview to create a comprehensive data lineage that visually tracks every source and transformation used in a given dataset. So, it is not only die hard data cleansing but there is also room to use other techniques like software and platform engineering.
the critical importance of cybersecurity and the significant impact it can have on individuals and organizations. Now I enjoy helping my clients navigate the complex and constantly evolving landscape by identifying potential risks, developing comprehensive security strategies and implementing effective controls.
What are you passionate about?
Have you run into issues along your career? How did you solve them?
Have you run into issues along your career? How did you solve them?
Have you run into issues along your career? How did you solve them?
What kind of technology do you use?
learn
the ropes quite quickly.”
It is my duty to help protect financial organizations against cyber threats. I believe that everyone has a right to privacy and security, and it is my duty to help protect individuals, organizations, and communities from cyber threats. ”I also have a strong belief in ethical behaviour and a commitment to doing what is right.” It’s important to maintain the highest standards of integrity, honesty and transparency and to act in the best interests of our clients at all times.
Every year, a lot of new tools and updates are released that are supposed to make the lives of a data engineer or a data scientist easier. Previously, I found it quite challenging to stay up to date with all these tools, as some work really well and continue to exist, while others miss the mark entirely. Now that I have a few regular blogs that I read from people in my field, I can keep up much easier with all these new changes. Have any questions regarding engineering? Feel free to come by one time for a chat!
Every year, a lot of new tools and updates are released that are supposed to make the lives of a data engineer or a data scientist easier. Previously, I found it quite challenging to stay up to date with all these tools, as some work really well and continue to exist, while others miss the mark entirely. Now that I have a few regular blogs that I read from people in my field, I can keep up much easier with all these new changes. Have any questions regarding engineering? Feel free to come by one time for a chat!
Every year, a lot of new tools and updates are released that are supposed to make the lives of a data engineer or a data scientist easier. Previously, I found it quite challenging to stay up to date with all these tools, as some work really well and continue to exist, while others miss the mark entirely. Now that I have a few regular blogs that I read from people in my field, I can keep up much easier with all these new changes. Have any questions regarding engineering? Feel free to come by one time for a chat!
At EY, “we have access to all kinds of cutting-edge technology and tools that enable me to stay ahead of emerging cybersecurity threats,” and help our clients manage their cybersecurity risk effectively.

What kind of technology do you use?
What kind of technology do you use?
What kind of technology do you use?
Interested in Tech at EY?
Interested in Tech at EY?
Interested in Tech at EY?
Ran into any issues during your career? How did you solve them?
My work involves a unique blend of modern technologies. I rely heavily on SQL and Python (PySpark) to carry out complex data operations such as ingestion, transformation, and serving. With a range of Azure tools at my disposal, my colleagues and I are currently building a
Working in a dynamic environment is one of the things I love about my job - no two days are ever the same. I thrive on the new learning experiences that each day brings, whether it’s meeting new people, working with diverse clients, or
My work involves a unique blend of modern technologies. I rely heavily on SQL and Python (PySpark) to carry out complex data operations such as ingestion, transformation, and serving. With a range of Azure tools at my disposal, my colleagues and I are currently building a
My work involves a unique blend of modern technologies. I rely heavily on SQL and Python (PySpark) to carry out complex data operations such as ingestion, transformation, and serving. With a range of Azure tools at my disposal, my colleagues and I are currently building a
How’d you get into Cyber?
I am an avid puzzle solver. I enjoy working on complex problems and finding creative solutions. This is actually what led me to pursue a career in cybersecurity. I am fascinated by the challenge
One of the challenges I experienced was managing a team of cybersecurity professionals with diverse backgrounds and skill sets. I learned that effective communication and collaboration are key to fostering a positive and productive team dynamic. I took the time to listen to each team member’s concerns and
Tech Consultants in the Spotlight
of protecting information and
“
It is my duty to help protect financial organizations against cyber threats.”
“
Sure, it can be challenging at times, but the sense of accomplishment when you meet a deadline or exceed expectations is second to none.
“
Sure, it can be challenging at times, but the sense of accomplishment when you meet a deadline or exceed expectations is second to none.
“
Sure, it can be challenging at times, but the sense of accomplishment when you meet a deadline or exceed expectations is second to none.
Thomas Boersma
EY Senior Consultant
Data Engineering
Thomas Boersma EY Senior Consultant Data Engineering
Thomas Boersma EY Senior Consultant Data Engineering

 Thomas Boersma
Thomas Boersma
EY Senior Consultant Data Engineering



How would you explain EY and the field you work in?
How would you explain EY and the field you work in?
How would you explain EY and the field you work in?
Currently, I am part of a project team of 10 colleagues, tackling a complex problem for a client spanning multiple countries. For this client, “I also had the opportunity to fly out to Rome and present our implemented solution to our client with the team.” Sure, the work can be challenging at times, but the sense of accomplishment when you meet a deadline or exceed expectations is second to none. Our team in the Netherlands consists of around 70 data scientists & engineers and are from various backgrounds, both technically and culturally, which results in a team with broad expertise, a pleasant atmosphere and great drinks on the Friday.
How would you explain EY and the field you work in? Currently, I am part of a project team of 10 colleagues, tackling a complex problem for a client spanning multiple countries. For this client, “I also had the opportunity to fly out to Rome and present our implemented solution to our client with the team.” Sure, the work can be challenging at times, but the sense of accomplishment when you meet a deadline or exceed expectations is second to none. Our team in the Netherlands consists of around 70 data scientists & engineers and are from various backgrounds, both technically and culturally, which results in a team with broad expertise, a pleasant atmosphere and great drinks on the Friday.
Currently, I am part of a project team of 10 colleagues, tackling a complex problem for a client spanning multiple countries. For this client, “I also had the opportunity to fly out to Rome and present our implemented solution to our client with the team.” Sure, the work can be challenging at times, but the sense of accomplishment when you meet a deadline or exceed expectations is second to none. Our team in the Netherlands consists of around 70 data scientists & engineers and are from various backgrounds, both technically and culturally, which results in a team with broad expertise, a pleasant atmosphere and great drinks on the Friday.
Currently, I am part of a project team of 10 colleagues, tackling a complex problem for a client spanning multiple countries. For this client, “I also had the opportunity to fly out to Rome and present our implemented solution to our client with the team.” Sure, the work can be challenging at times, but the sense of accomplishment when you meet a deadline or exceed expectations is second to none. Our team in the Netherlands consists of around 70 data scientists & engineers and are from various backgrounds, both technically and culturally, which results in a team with broad expertise, a pleasant atmosphere and great drinks on the Friday.
everything runs smoothly.Throughout the day, I’m always available to answer any questions my colleagues have and review pull requests when needed. It’s a busy and challenging job, but I love it!
everything runs smoothly.Throughout the day, I’m always available to answer any questions my colleagues have and review pull requests when needed. It’s a busy and challenging job, but I love it!
everything runs smoothly.Throughout the day, I’m always available to answer any questions my colleagues have and review pull requests when needed. It’s a busy and challenging job, but I love it!
everything runs smoothly.Throughout the day, I’m always available to answer any questions my colleagues have and review pull requests when needed. It’s a busy and challenging job, but I love it!
Tell us something about yourself and how you got into Data?
Tell us something about yourself and how you got into Data?
Tell us something about yourself and how you got into Data?
Tell us something about yourself and how you got into Data?
What’s your day to day as a Data Engineer?
What’s your day to day as a Data Engineer?
your day to day as a Data Engineer?
What’s
What’s your day to day as a Data Engineer?
Every day is different, and we’re always helping out other teams. But let me try to walk you through what a day looks like. First, I start off with our daily stand up where we catch up on what each team member worked on the previous day and assign new tasks for the day ahead.
Every day is different, and we’re always helping out other teams. But let me try to walk you through what a day looks like. First, I start off with our daily stand up where we catch up on what each team member worked on the previous day and assign new tasks for the day ahead. After that, I usually have a meeting with clients to discuss various data sources and validate the data while ensuring we’re following the right business rules. Armed with this information, we dive into building pipelines and scripts to make sure
Every day is different, and we’re always helping out other teams. But let me try to walk you through what a day looks like. First, I start off with our daily stand up where we catch up on what each team member worked on the previous day and assign new tasks for the day ahead. After that, I usually have a meeting with clients to discuss various data sources and validate the data while ensuring we’re following the right business rules. Armed with this information, we dive into building pipelines and scripts to make sure
Every day is different, and we’re always helping out other teams. But let me try to walk you through what a day looks like. First, I start off with our daily stand up where we catch up on what each team member worked on the previous day and assign new tasks for the day ahead. After that, I usually have a meeting with clients to discuss various data sources and validate the data while ensuring we’re following the right business rules. Armed with this information, we dive into building pipelines and scripts to make sure
At the age of 14, I developed an interest in programming because I was fascinated by coding and enjoyed creating things from scratch. Naturally, this led me to pursue a bachelor’s degree in Software Engineering with a minor in Data Science. Although my initial career path was focused on software engineering, I became interested in big data after reading some books about it. Consequently, I transitioned into a role as a Data Engineer, and found the transition to be relatively smooth - ”with a bit of techsavvy knowhow and if you relish a good challenge, anyone can learn the ropes quite quickly.”
At the age of 14, I developed an interest in programming because I was fascinated by coding and enjoyed creating things from scratch. Naturally, this led me to pursue a bachelor’s degree in Software Engineering with a minor in Data Science. Although my initial career path was focused on software engineering, I became interested in big data after reading some books about it. Consequently, I transitioned into a role as a Data Engineer, and found the transition to be relatively smooth - ”with a bit of techsavvy knowhow and if you relish a good challenge, anyone can learn the ropes quite quickly.”
At the age of 14, I developed an interest in programming because I was fascinated by coding and enjoyed creating things from scratch. Naturally, this led me to pursue a bachelor’s degree in Software Engineering with a minor in Data Science. Although my initial career path was focused on software engineering, I became interested in big data after reading some books about it. Consequently, I transitioned into a role as a Data Engineer, and found the transition to be relatively smooth - ”with a bit of techsavvy knowhow and if you relish a good challenge, anyone can learn the ropes quite quickly.”
At the age of 14, I developed an interest in programming because I was fascinated by coding and enjoyed creating things from scratch. Naturally, this led me to pursue a bachelor’s degree in Software Engineering with a minor in Data Science. Although my initial career path was focused on software engineering, I became interested in big data after reading some books about it. Consequently, I transitioned into a role as a Data Engineer, and found the transition to be relatively smooth - ”with a bit of techsavvy knowhow and if you relish a good challenge, anyone can learn the ropes quite quickly.”
What kind of technology do you use?
complete data lakehouse from scratch. To ensure the project is a success, we’re using Azure Purview to create a comprehensive data lineage that visually tracks every source and transformation used in a given dataset. So, it is not only die hard data cleansing but there is also room to use other techniques like software and platform engineering.
complete data lakehouse from scratch. To ensure the project is a success, we’re using Azure Purview to create a comprehensive data lineage that visually tracks every source and transformation used in a given dataset. So, it is not only die hard data cleansing but there is also room to use other techniques like software and platform engineering.
complete data lakehouse from scratch. To ensure the project is a success, we’re using Azure Purview to create a comprehensive data lineage that visually tracks every source and transformation used in a given dataset. So, it is not only die hard data cleansing but there is also room to use other techniques like software and platform engineering.
complete data lakehouse from scratch. To ensure the project is a success, we’re using Azure Purview to create a comprehensive data lineage that visually tracks every source and transformation used in a given dataset. So, it is not only die hard data cleansing but there is also room to use other techniques like software and platform engineering.
Have you run into issues along your career? How did you solve them?
Have you run into issues along your career? How did you solve them?
Have you run into issues along your career? How did you solve them?
Have you run into issues along your career? How did you solve them?
Every year, a lot of new tools and updates are released that are supposed to make the lives of a data engineer or a data scientist easier. Previously, I found it quite challenging to stay up to date with all these tools, as some work really well and continue to exist, while others miss the mark entirely. Now that I have a few regular blogs that I read from people in my field, I can keep up much easier with all these new changes. Have any questions regarding engineering? Feel free to come by one time for a chat!
Every year, a lot of new tools and updates are released that are supposed to make the lives of a data engineer or a data scientist easier. Previously, I found it quite challenging to stay up to date with all these tools, as some work really well and continue to exist, while others miss the mark entirely. Now that I have a few regular blogs that I read from people in my field, I can keep up much easier with all these new changes. Have any questions regarding engineering? Feel free to come by one time for a chat!
Every year, a lot of new tools and updates are released that are supposed to make the lives of a data engineer or a data scientist easier. Previously, I found it quite challenging to stay up to date with all these tools, as some work really well and continue to exist, while others miss the mark entirely. Now that I have a few regular blogs that I read from people in my field, I can keep up much easier with all these new changes. Have any questions regarding engineering? Feel free to come by one time for a chat!
What kind of technology do you use?
What kind of technology do you use?
My work involves a unique blend of modern technologies. I rely heavily on SQL and Python (PySpark) to carry out complex data operations such as ingestion, transformation, and serving. With a range of Azure tools at my disposal, my colleagues and I are currently building a
What kind of technology do you use?
My work involves a unique blend of modern technologies. I rely heavily on SQL and Python (PySpark) to carry out complex data operations such as ingestion, transformation, and serving. With a range of Azure tools at my disposal, my colleagues and I are currently building a
My work involves a unique blend of
Interested in Tech at EY?
Interested in Tech at EY?
My work involves a unique blend of modern technologies. I rely heavily on SQL and Python (PySpark) to carry out complex data operations such as ingestion, transformation, and serving. With a range of Azure tools at my disposal, my colleagues and I are currently building a
Every year, a lot of new tools and updates are released that are supposed to make the lives of a data engineer or a data scientist easier. Previously, I found it quite challenging to stay up to date with all these tools, as some work really well and continue to exist, while others miss the mark entirely. Now that I have a few regular blogs that I read from people in my field, I can keep up much easier with all these new changes. Have any questions regarding engineering? Feel free to come by one time for a chat!
Interested in Tech at EY?
Interested in Tech at EY?

modern technologies. I rely heavily
“ Sure, it can be challenging at times, but the sense of accomplishment when you meet a deadline or exceed expectations is second to none.
After that, I usually have a meeting
“
Sure, it can be challenging at times, but the sense of accomplishment when you meet a deadline or exceed expectations is second to none.
“
Sure, it can be challenging at times, but the sense of accomplishment when you meet a deadline or exceed expectations is second to none.
“
Sure, it can be challenging at times, but the sense of accomplishment when you meet a deadline or exceed expectations is second to none.
Reporting for duty.
Reporting for duty.
Damen Naval is the dedicated naval shipbuilding division of the Damen Shipyards Group, which brings together all the naval activities of the group, both in the Netherlands and abroad.
Damen Naval is the dedicated naval shipbuilding division of the Damen Shipyards Group, which brings together all the naval activities of the group, both in the Netherlands and abroad.

With roots stretching back almost 150 years – to the Royal Schelde yard in Vlissingen – Damen Naval is the only naval original equipment manufacturer (OEM) in the Netherlands.
With roots stretching back almost 150 years – to the Royal Schelde yard in Vlissingen – Damen Naval is the only naval original equipment manufacturer (OEM) in the Netherlands.
Having delivered more than 400 vessels to customers all around the world, we are a trusted partner in the international marketplace.
Having delivered more than 400 vessels to customers all around the world, we are a trusted partner in the international marketplace.
Find out more on career.damen.com
Find out more on career.damen.com
Check the video on our YouTube channel


Check the video on our YouTube channel
























 Arjenne Louter, the Dutch PhD Coach
Arjenne Louter, the Dutch PhD Coach

TCPM ACADEMY
ABOUT TCPM
TCPM ACADEMY
ABOUT TCPM









 Osse farmacluster
Osse farmacluster


 #inBrabant
#inBrabant

















 Optical Engineer
Hue SW Product Owner
Optical Engineer
Hue SW Product Owner








































































































































































































































































 Thomas Boersma
Rabab Laarabi EY Manager
Thomas Boersma
Rabab Laarabi EY Manager





